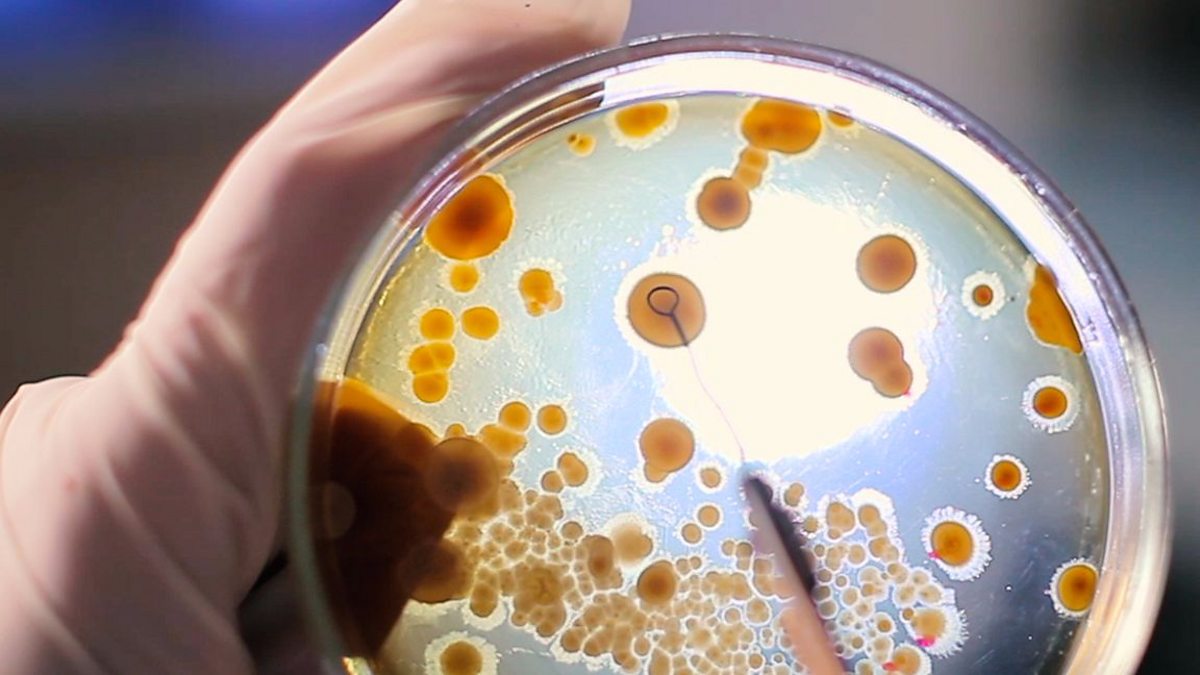

Navigation
Navigation


Moving beyond simple deficiency prevention to explore how optimal macronutrient intake actively extends long term physical healthspan

How the same neurological satiety signaling that calms compulsive eating can dangerous activate a dormant restrictive disorder

Exploring the deeply ingrained evolutionary drives and neural circuitry that govern modern human appetite and food choices

Unpacking how metabolic transitions into ketosis can directly alter brain bioenergetics and stabilize severe mood fluctuations

Moving beyond the quick fix narrative to examine the profound shift in food reward neurobiology and emotional eating patterns

Early exposure to ultra-processed food leaves lasting imprints on neurological pathways and alters lifelong behavioral choices

Exploring the circadian mismatch where inconsistent eating schedules disrupt metabolic rhythms and elevate clinical depression risks

A deep dive into the enteric nervous system, revealing how poor dietary habits directly degrade the neural networks of the gut.

From recognition to response: Practical, evidence-based communication tools to bridge the gap between warning signs and clinical care.

New large-scale data reveals how synthetic hormone phases in combined birth control pills can trigger neurobehavioral surges in emotional eating.

Exploring how our vital chemosensory pathways quietly anchor human emotional stability and daily connection to the world

New data reveals how intense sociocultural body ideals can alter basic cognitive and temporal processing of food cues in adolescents

Beyond body image: exploring the complex interplay of hormonal shifts and identity transitions in maternal psychological health.

Cultivating a healthy information diet: why the polarization of social feeds demands a deliberate shift toward psychological nuance.

Moving beyond willpower: how clinical data and GLP-1 mechanisms reframe persistent food thoughts as biological rather than moral.

New clinical data underscores the critical role of psychological protocols in treating disorders of gut-brain interaction.

Though chemically calorie-free, non-nutritive sweeteners present clear biological risks to executive function and microbial health.

Acting more like a neurohormone than a simple nutrient, vitamin D plays an essential role in modulating mood stability and memory.

Narrative review explores how industrially altered ingredients sensitize reward pathways, driving cravings and loss-of-control eating.

New MRI analysis highlights how everyday dietary habits directly correlate with the volume and connectivity of essential neural structures.

New data validates tools to measure intrusive eating thoughts, showing how clinical and behavioral therapies ease cognitive load.

Why modern hyper-palatable processed foods exploit our ancient survival instincts to cause an evolutionary dietary mismatch.

New tissue data shows how high-saturated fat intake damages enteric neurons, directly impairing gastrointestinal motility.

Evidence highlights how metabolic shifts, systemic inflammation, and gut-health imbalances influence skin disease severity.

Cross-sectional data reveals that even modest increases in ultra-processed intake induce measurable declines in mental processing speed.

Research reveals that distinct metabolic and hormonal differences make female brain health significantly more sensitive to dietary intake.

Lancet study marks an unprecedented surge in global illness, with psychiatric burden peaking among youth ages 15 to 19 for the first time.

The study reveals a crucial distinction: plant-based nitrates protect cognition, whereas inorganic and synthetic sources pose risks.

New data underscores the power of integrating structural nutritional aid with targeted, trust-based behavioral coaching.

Animal models show switching to healthy chow partially restores memory loss, though long-term cognitive damage may persist.

New study links irregular meal schedules to a 55% higher risk of depressive symptoms, pointing to circadian and metabolic disruption.

Comprehensive data tracking suggests alcohol consumption may upregulate FGF21, a hormone that actively drives savory food preferences.

Mapping how energy restriction in patients with obesity simultaneously alters gut microbes and reduces addiction-related brain activity.

A new systematic review maps how paternal preconception health and epigenetic markers shape a child’s metabolic trajectory.

Examining how the cessation of anti-obesity medications triggers intense relapse anxiety and exposes underlying body image wounds.

A systematic review of 73 studies highlights how nutritional foundations in infancy dictate cognitive health years later.

Exploring why the brain’s mental model of the body lags behind rapid physical changes driven by modern medical interventions.

New publication links socioeconomic security and social isolation to shifts in gut motility, visceral sensitivity, and microbiota.

Comprehensive meta-analysis of 730,000 participants reveals that chronic constipation is tied to twofold higher odds of depression.

Supervised 14-week trial shows 72% of completers achieved full symptom remission without weight loss, offering a new path for relapse.

Experimental data reveals that hunger directly alters the speed and vividness of mental imagery, making cravings harder to manage.

As clinical boundaries fade, automated prescribing shifts the use of metabolic drugs from treating chronic disease to managing body anxiety.

National survey shows 70% of adults view UPFs as addictive, ranking their health risk as equivalent to alcohol and worse than cannabis.

New trial suggests targeting metabolic dysfunction with high-fat, low-carb therapy can regulate persistent psychological symptoms.

Massachusetts Medicaid study links dietitian-designed meal delivery to 31% fewer hospitalizations and rapid cost reduction.

Beyond weight management: What upcoming phase 3 trial readouts will reveal about the gut-brain axis and reward-center regulation.

Evaluating how ultra-processed food formulations engage mesolimbic dopamine signaling to override normal satiety pathways.

Analyzing how saturable intestinal transporters cause fructose spillover, altering gut microbiota to trigger mood changes.

Preclinical data suggests memory impairments induced by high-sugar diets persist even after returning to healthy eating.

Dietary choline, carotenoids, and phospholipids found in eggs appear to strengthen memory and protect synaptic health.

How labor market demands and systemic time poverty alter our daily food environments, fueling chronic metabolic dysfunction.

New pediatric data reveals the negative psychological impact of ultra-processed snacks outweighs the benefits of a clean diet.

Beyond vegans and meat enthusiasts: How can behavior design unlock the hidden potential of the mainstream majority?

Elevated homocysteine levels reveal a biological link between subclinical B12 and folate gaps and systemic exhaustion.

Both clinical anorexia and GLP-1 use can blunt interoceptive awareness, silencing the brain-body signals required for nourishment.

Amid rising fresh produce prices, simple liquid interventions serve as an affordable, accessible tool to bridge nutritional gaps.

Mayo Clinic podcast data highlights nutrition as a supportive clinical adjunct—not an independent cure—for mental illness.

Fueling weight gain and metabolic strain, chronic overtime overpowers individual willpower by shifting dietary choices.

Large-scale data shows how erratic meal schedules disrupt circadian rhythms and the stress hormones tied to mood disorders.

A 50-year study review shows how hyper-engineered food designs, not just psychological factors, trigger overconsumption.

Systematic data reinforces the gut-brain axis, proving that reducing intestinal inflammation preserves cognitive performance.

While offering metabolic benefits, the rise of appetite-suppressing drugs highlights an urgent need for eating disorder screenings.

Cooking at home fosters a mindful connection to wellness while actively reducing exposure to ultra-processed ingredients.

Neurological patterns in youth with elevated body weight reveal reduced impulse control, potentially cementing difficult dietary habits.

Large-scale occupational study highlights the mental health value of incorporating culturally tailored, nutrient-dense nutrition.

While peer networks can accelerate the spread of disordered eating behaviors, they also hold the key to cultivating collective resilience.

Trial finds psychological distress decreases when adopting a Mediterranean pattern, driven largely by the process of self-care.

A new randomized controlled trial will utilize neuroimaging to evaluate if altered brain energy metabolism can prevent symptom progression.

New clinical data confirms that otherwise pristine eating habits hit a biological ceiling when attempting to neutralize ethanol damage.

Emerging clinical data suggests GLP-1 drugs alter dopamine signaling, muting enthusiasm for everyday pleasures beyond food.

A new meta-analysis reveals that while the brain can bounce back from fat, added sugar leaves permanent scars on memory circuits.

Acting as a localized blood pump, mastication can increase cerebral circulation by up to 28%, supplying critical oxygen to the brain.

Modern food additives create ambiguous chemical signals in the gut, disrupting the vital microbial messages that shape our mood.

Clinical data highlights a complex, two-way relationship where metabolic stress worsens mood, and low mood impairs metabolic control.

Emerging data reveals how eating after 9 p.m. disrupts circadian rhythms, compounding the physiological damage of chronic stress.

A new study highlights how fiber, folate, magnesium, and selenium actively support critical biological pathways linked to mood regulation.

Mainstream anti-obesity drugs face cultural backlash, as critics dismiss pharmaceutical interventions as the "easy way out."

Quality sleep serves as a vital biological buffer that helps a healthy diet protect the brain from the metabolic wear of chronic stress.

High protein diets support glycemic control and satiety through cost effective staples like eggs and nutrient dense canned legumes.

New data shows a keto diet boosts T-cells to regulate the immune system and naturally combat muscle weakness in myasthenia gravis.

New research suggests that a lower fat plant forward diet can slow down biological aging by improving cellular and epigenetic health.

Medical nutrition therapy and exercise are now deemed essential components for patients using new weight loss drugs to maintain safety.

Combining GLP-1 drugs with lifestyle changes offers a dual pathway to quiet food noise and break addictive dopamine-driven cycles

Intrusive food noise drives compulsive habits by using dopamine to override satiety, making it harder to sense true physical hunger.

Beyond serotonin: A new meta-analysis links low brain choline levels to anxiety disorders, highlighting a vital nutrient-mood connection.

New FHI review: Evidence for eating disorder prevention remains fragmented despite rising cases globally.

Social media exposure to "junk food" messages outpaces healthy content, significantly impacting the dietary choices of Australian teens.

Does social anxiety dictate your diet? Study links FoMO to heightened reward-driven eating patterns and addictive food behaviors.

Moving past prohibition: why experts argue that understanding patient psychology is vital to prevent depression in nutritional care.

New research links frequent egg intake to reduced Alzheimer’s risk, highlighting the role of nutrient-dense foods in brain longevity.

Evidence suggests fermented kimchi strengthens immune activity, with genetic analysis showing its power to balance systemic resilience.

Recent findings from Spain underscore the complex, ongoing challenges affecting long-term well-being in celiac disease.

GLP-1 treatments prove more effective for individuals driven by external food cues than for those who utilize eating as an emotional coping tool.

Incorporating short intervals of activity may be a powerful tool for stabilizing blood sugar levels during long periods of sitting.

New research suggests that using GLP-1 medications for weight loss may carry a higher social stigma than traditional lifestyle changes.

Virginia Tech scientists aim to uncover how metabolic health influences the subconscious brain processes governing eating behaviors.

Combining elevated stress with nocturnal eating habits creates a disruptive environment for your digestive system and gut health.

Understanding food therapy requires decoding the biological link between stress processing and disordered eating patterns.

GLP-1 drugs like semaglutide (Ozempic, Wegovy) may improve mental health, with fewer psychiatric visits and sick days.

Beyond physical hunger: Exploring the psychological drivers of constant food-related thoughts and their role in metabolic health.

Beyond the home: research identifies how weight-based teasing from various relatives correlates with internalized stigma in youth.

New research suggests fish oil may not always aid brain repair; in specific contexts, EPA could potentially hinder neural healing.

Comprehensive research clarifies that meat intake lacks a definitive link to depression, shifting our focus to other dietary factors.

New research links ultra-processed foods to cognitive decline. Explore the critical intersection of nutrition and brain health.

Data from Digestive Disease Week reveals how the cumulative toll of stress amplifies the negative impact of late-night food intake.

Research maps how coffee compounds—like polyphenols—target the gut-brain axis to enhance memory and reduce anxiety.

Investigating the link between central adiposity and the chronic inflammation that triggers depressive symptoms in older adults.

Identifying the hindbrain neurons that act as a command center, translating liver signals into immediate shifts in food choice.

How Humanin and SHMOOSE—tiny proteins triggered by healthy fats—shield the brain from oxidative stress and cognitive decline.

Analyzing the "What the Hell Effect"—how prolonged stress collapses healthy routines and triggers a cycle of nutritional neglect.

New longitudinal data reveals that even minor daily increases in ultra-processed intake can measurably diminish cognitive focus.

Moving past dietary habits to address the profound emotional and psychological struggles at the heart of disordered eating.

Research indicates that local economic conditions and education levels account for the vast majority of geographic mental health gaps.

Discover how misaligned meal timing can amplify the negative impact of psychological stress on the gut microbiome and overall health.

Investigating the "anhedonic" effect: An analysis of how metabolic interventions can influence broader emotional and hedonic states.

Explore the neurobiological roots of intrusive cravings and why persistent food thoughts are a clinical reality, not a willpower gap.

Exploring how specific nutrient densities and stable glucose levels support executive function and symptom management in ADHD brains.

Evidence reveals how consistent exercise physically reconfigures the stress response, fostering long-term neurobiological resilience.

Clinical insights on why GLP-1 success depends on preventing muscle loss and nutrient gaps through expert-led nutritional protocols.

How do GLP-1s reshape self-perception? Examining the profound link between metabolic medication and psychological body image.

AI-driven discovery: Stanford scientists identify "BRP," a natural peptide that mimics weight loss effects without typical side effects.

Beyond calories: New research suggests refined bread triggers weight gain by significantly slowing basal metabolic rates and energy expenditure.

Beyond the plate: While results vary for anxiety, anti-inflammatory eating patterns offer a significant signal for depression remission.

Optimize your cognitive longevity and brain health through a selection of evidence-based nutrients for peak mental performance.

Stress and burnout drive eating disorders and food guilt, proving that mental health is the foundation of a healthy relationship with food.

What you eat shapes your emotions; new research proves specific dietary patterns can actively reduce risks of depression and anxiety.

A landmark study finally defines "mental well-being," creating a universal scientific standard for what it truly means to be well.

Cutting sugar isn't just for your body—it’s for your mind. New research links high sugar intake to increased risk of depression and anxiety.

Beyond physical weight loss, GLP-1 medications can deeply impact adolescent emotional well-being and psychological health in complex ways.

Antibiotic use during pregnancy is linked to higher psychological distress, highlighting the gut-brain axis's role in maternal health.

Lancet series on ultra-processed foods (UPFs) shows global evidence on the health, economic, and societal impact of UPFs

Reshaping the gut microbiome could help protect brain function, timing may be critical

An interview with Felice Jacka, OAM, PhD, on the rapidly developing field of nutritional psychiatry.

Research indicates color coding is more effective than nutritional tables due to the way the brain responds to benefit and risk signals

Study shows modulating the gut microbiome may slow cognitive decline and improve brain health

A 3-week study exploring an ultra-processed food diet found impaired metabolic and reproductive health

As the popularity of GLP-1 weight loss drugs continues to rise, people on red carpets, screens and on social media continue to get smaller

Integrating metabolic interventions into psychiatric care offers new hope for treating schizophrenia, bipolar disorder, and depression.

Sticking to meal repetition and steady calories helps weight loss, but higher weekend intake was also linked to better results in a new study.

Increasingly, research links an anti-inflammatory diet, specifically one rich in omega-3s, to significantly better mental well-being.

Healthy dietary patterns, rather than single nutrients, are consistently linked to fewer depressive symptoms in teens, new research shows.

While many interventions aim to cut meat intake for health and the environment, finding a truly effective psychological nudge remains elusive.

Nature exposure may be the secret to a better diet, as new research suggests time spent outdoors naturally nudges you toward healthier food.

Sleep timing, not just duration, drives how teens eat and move: "night owls" consume more calories and are more sedentary than early risers.

Cooking at home from scratch even once a week can slash dementia risk by 67%, especially for those with fewer skills, new research shows.

New research shows the DASH diet offers the strongest protection against cognitive decline, proving diet is key to brain health.

Even when you know it's a fake, the placebo effect can boost physical and mental health in older adults, a new Milan study reveals.

A high-meat diet may uniquely protect the brain and lower mortality for those with the high-risk Alzheimer's gene, APOE4/4.

Meal repetition and steady calories boost weight loss by reducing "decision fatigue" and dietary slip-ups, new APA research shows.

Step outside to eat better! Nature exposure reduces stress and naturally nudges you toward choosing more fruits and vegetables.

Forget willpower! New research suggests that reshaping a child's environment is far more effective than "muscle-like" self-control.

Higher ultra-processed food intake is linked to a greater long-term risk of ASCVD, with a stronger association among Black participants.

One year later, we are discovering that GLP-1s are more complex than just "easy weight loss," revealing new uses, side effects, and trends.

Pediatricians can use quick screenings and policy advocacy to help families swap ultra-processed foods for healthier, whole alternatives.

Unlock your mental flexibility: Breakfast, exercise, and deep sleep are the ultimate tools to adapt to stress and stay mentally agile.

The MIND diet—merging Mediterranean and DASH principles—can slow brain aging by over two years by prioritizing berries and leafy greens.

Early life stress can trigger lifelong digestive issues by reshaping the gut and sympathetic nervous systems, a new study reveals.

GLP-1 and semaglutide drugs effectively reduce obesity, but they aren't a quick fix; understanding risks is key to informed choice.

A mouse study reveals gut bacteria can reach the brain via the vagus nerve, bypassing the blood and reshaping our view of gut-brain health.

Drexel University research links time spent in nature to better dietary choices, including higher intake of fruits and vegetables.

UPF intake in preschoolers is linked to higher behavioral and emotional risks, but replacing them with whole foods improves outcomes.

Sustainable eating and the DASH diet are powerful tools for preserving cognitive vitality and fighting depression as we age.

A study in PLOS Biology reveals that bacteria can travel from the gut to the brain when the intestinal barrier is weak, impacting neurological health.

King's College London research links excessive smartphone use to emotional overeating and food addiction symptoms in young people.

While case studies show that ketogenic diets may help some with schizophrenia, high-quality research for severe mental illness is still lacking.

A family conflict over gluten-free food underscores how celiac disease misunderstandings cause emotional stress and serious health risks.

A new study suggests high-fat diets allow live gut bacteria to travel via the vagus nerve directly into the brain, potentially triggering neurological conditions.

Fructose malabsorption is linked to body-wide inflammation and anxiety, as undigested sugar alters gut bacteria and impacts the brain.

The new US dietary guidelines through 2030 prioritize "real food" over ultra-processed snacks to curb chronic disease and healthcare costs.

Oprah Winfrey’s weight journey highlights a cultural obsession with thinness and the pervasive impact of weight stigma on women.

Yale research suggests that lowering parental stress is a critical third factor, alongside diet and exercise, to prevent childhood obesity.

A 2026 study found that eating ultra-processed foods at age three is linked to behavioral issues by age five, while whole foods help.

A new study suggests that overall diet quality, rather than ultra-processed food intake, is the primary driver of cognitive health in older adults.

Stress impacts gut health via the brain-gut axis; choosing nutrient-dense foods over sugary snacks better manages this stress response.

Anxiety levels may be closely tied to dietary choices, as a new study reveals a surprising link between your plate and your brain.

Gut health and brain function may suffer due to emulsifiers, which thin the protective mucus layer and disrupt microbial balance.

A decade-long study of 40,000 women suggests that flavonoid-rich foods like berries and citrus are linked to higher levels of optimism.

Children in Canada who consume more ultra-processed foods at age three show higher risks of behavioral and emotional issues by age five.

A new study in Tokyo suggests that children who eat vegetables first may develop significantly higher resilience and self-esteem.

A 14-country study reveals that 70% of people with obesity face a life-wide impact, yet most still internalize blame and stigma.

New research from Flinders University shows that chronic dieters are far more likely to grab unhealthy snacks when stressed or sad.

New research links high consumption of ultra-processed foods in early childhood to increased risks of anxiety, hyperactivity, and aggression.

Brief bursts of high-sugar, high-fat snacking can rewire the brain's insulin response before any weight gain even appears.

GLP-1 access carries a heavy psychological weight, as using these drugs for thinness can trigger body shame and mask eating disorders.

Experts from George Mason University highlight that ultra-processed diets are a dual crisis, damaging both human health and the environment.

Magnesium is viral for sleep and mood, but the real key is knowing its true functions, food sources, and if supplements are necessary.

Compulsive eating stems from a brain-level clash between reward and metabolic signals, not just a lack of willpower.

Your mindset around eating reveals the depth of your relationship with food; here is how to identify and heal unhealthy patterns.

Ramadan can be a mirror for intention, redefining self-care and faith beyond the pervasive lens of modern diet culture.

Beyond poor diet, early smartphone use and weakening social and spiritual bonds are driving a mental health crisis among India’s youth.

Adopting a whole-food plant-based diet shows significant promise in stabilizing mood disorders and slashing long-term dementia risk.

Social media algorithms frequently blend recovery and diet content, creating a confusing and high-risk digital environment for vulnerable users.

A global study reveals India’s youth are struggling mentally, with surging UPF intake and screen time identified as critical risk factors.

Nearly half of Americans buy takeout for comfort, while 67% turn to snacks and treats to lift their mood, driving a cycle of UPF use.

New research reveals that even unmotivated young adults can be engaged in healthy eating through targeted, relatable communication strategies.

APA Publishing’s new collection explores critical frontiers, from the gut-brain axis in nutrition to the neurology-psychiatry overlap.

While early high-sugar diets can permanently disrupt adult appetite, specific probiotics and prebiotics show potential to reverse these brain changes.

Early-life high-fat, high-sugar diets may permanently scar the brain's hypothalamus, driving unhealthy overeating even after weight loss.

New research links meal skipping and low dairy intake to a significantly higher risk of depression during adolescent pregnancy.

Brie Reid's study shows infant stress like neglect correlates with highly inflammatory dietary choices and cravings in young adulthood.

Lucy Loch’s research reveals a hidden UPF addiction in 1 in 8 older adults, linking modern diets to isolation and the brain's reward system.

In just three days, a fiber-deficient diet can trigger neuroinflammation and impair the amygdala, the brain's emotional memory center.

A highly processed diet is linked to memory problems and inflammation in the aged brain – and the effect can happen just three days of poor eating

A lack of fiber may trigger rapid inflammation and memory issues in the aged brain, similar to the damage caused by ultra-processed foods.

Providers must understand how GLP-1 drugs can trigger relapse or hide eating disorders, ensuring safer support for vulnerable patients.

Adhering to healthy eating patterns may extend your life by several years, regardless of your genetic predisposition, a major study finds.

Toddlers eating ultra-processed foods at age two score significantly lower on IQ tests by ages six and seven, a Brazilian study finds.

Routine screening for eating disorders is a vital clinical skill, as these symptoms often remain hidden behind anxiety or trauma.

Örebro University research shows that probiotic delivery methods influence whether the brain benefits for memory or depression.

New data shows that dietary patterns at age 2, specifically ultra-processed food intake, impact cognitive performance at ages 6 and 7.

Bournemouth University researchers linked high-sugar drinks to teen anxiety after reviewing data from several diet and mental health studies.

Beyond treats like chocolate, food serves as a deep-seated language of love and human connection, says Prof. Evangeline Mantzioris.

Gemini said Lisa Du Breuil and Rachel Millner warn that depression and mental health issues can emerge after the bariatric surgery "honeymoon period."

UPFs are linked to 32 health risks, yet they make up half our calories; here is what happened during a one-week UPF-free challenge.

A Consumer Reports study warns that some popular protein powders and shakes contain high lead levels despite their rising popularity.

Clinicians are debating how to integrate nutrition into standard care as a vital pillar alongside traditional drugs and therapy.

New U.S. guidelines urge cutting ultra-processed foods and sugar, but warn "sugar-free" labels often hide alternative sweeteners.

While low-carb, high-fat diets may reduce schizophrenia symptoms, experts warn that labeling this approach a "cure" is misleading.

Stopping GLP-1 drugs often triggers weight regain as the body’s natural mechanisms fight to restore its previous set point.

Research shows ultra-processed foods can rewire the brain's reward system, making food addiction a real neurobiological phenomenon.

Research links ultra-processed foods to depression and brain inflammation, suggesting whole foods better support mental well-being.

What we eat builds more than just muscle; it fuels our emotional resilience and mental well-being, per Dr. William Compton.

High-salt diets trigger anxiety and cognitive decline by disrupting the gut-brain axis, new research reveals.

Swansea University researchers have launched a new roadmap to investigate the critical link between adolescent diet and mental health.

Chris and Sara Brownlow’s Navan workshops teach how fermentation and sourdough improve gut health and wellbeing.

Adhering to a Mediterranean diet lowers MS risk, particularly for nonsmokers and individuals under 45.

A landmark clinical trial is now pitting the ketogenic diet against standard NHS guidelines to see which better conquers bipolar depression.

Diet influences mental health through inflammation and the gut-brain axis, with key nutrients supporting women’s hormonal and emotional stability.

Implementing a medical ketogenic diet under professional guidance led to a rapid, life-changing reduction in schizophrenia symptoms.

To simplify healthy eating, researchers have ranked seven top raw foods that provide the best balance of essential nutrients.

WHO has designated the DTU National Food Institute as a new collaborating center on the risks and benefits of foods and diets.

New neuroscience research suggests that clues to our cravings and eating behavior may lie in a tiny, unexpected brain.

Experts say the rising obesity trend can be reversed through lifestyle education and better access to healthy food.

A new study found that weekly school gardening and nutrition classes improved children’s diets, boosted fiber intake, and reduced BMI.

Researchers report that higher blood glucose levels after meals are linked to increased dementia risk.

WHO urges healthier school food environments to promote nutritious choices and reduce diet-related health inequalities.

Type 1 diabetes combined with disordered eating poses serious health risks, highlighting the need for informed clinical management and communication.

Eating more ultra-processed foods may come at a mental cost, with new research linking them to poorer well-being and depression.

Watching Mukbang videos may reduce eating disorder symptoms, challenging assumptions about their harm.

When traditional treatments fall short, research shows diet and lifestyle can significantly support mental health and prevent disorders.

Quality of life, well-being, and emotional balance are strongly influenced by diet and lifestyle

Mindful eating goes beyond dieting—discover its true meaning, why dietitians recommend it, and easy, practical ways to practice it.

Research shows that reducing ultra-processed foods leads people to eat larger portions, feel more satisfied, and consume fewer calories.

Clinicians warn that GLP-1 drugs like Ozempic may trigger eating disorder relapses or new food-related struggles in some users.

Research shows that healthy diets rich in fruits and vegetables can help reduce depression.

A pilot study found that a supervised ketogenic diet alongside standard care reduced depressive symptoms by about 70% in college students.

A new article explains how packing a strategic lunchbox with balanced meals, hydration, and whole foods can help sustain focus, boost productivity, and prevent afternoon energy slumps.

A study finds people often turn to takeaway meals as a treat or a pick-me-up, showing how emotions subtly drive food choices.

A study shows that eating mostly whole, minimally processed foods lets people eat more volume while consuming fewer calories than ultra-processed diets.

A BBC Future article explains how the health benefits of foods change as we age, making some nutrients more important at different life stages.

Dental caries—the world’s most common noncommunicable disease—is preventable, yet remains widespread due to high free sugar intake.

Small increases in sleep, healthier foods, and daily exercise can meaningfully boost health and longevity.

Could certain foods and dietary patterns help prevent or slow these issues from occurring?

New study indicates that specific eating habits may provide broad protection against a variety of brain diseases.

The new guidelines prioritize healthy fats and proteins while advising a limit on saturated fat intake.

Beyond stereotypes, eating disorders affect 4.5% of Australians including all ages and genders, with high risks for LGBTQIA+ individuals.

New findings suggest the MIND diet reduces Alzheimer’s biomarkers in midlife, offering early protection against future cognitive decline.

U.S. food regulation may soon transition from monitoring ingredients to overseeing the processing methods used for UPFs.

A study in mice found that adding fruits and vegetables to a high-fat diet prevents memory loss and cognitive decline.

In mice, C-section delivery alters brain barrier structure and immune function, potentially impacting early neurodevelopmental trajectories.

For students with overweight or obesity, improving diet and stress management is essential for better physical and emotional health.

New research suggests that the quality and quantity of dietary carbohydrates have a significant impact on dementia development

New study provides evidence that consuming refined diets for as little as three days can lead to memory impairments in the aging brain

A new study finds that women who ate probiotic yoghurt daily for eight weeks showed changes in brain function linked to mood and memory.

Guidelines prioritize high-quality protein, healthy fats, fruits, vegetables and whole grains and avoid highly processed foods and refined carbohydrates.

A new study links specific gut bacteria to depression and Alzheimer's by showing how these microbes alter blood lipids to influence brain health.

Impulsive individuals are more likely to act rashly during emotional lows, significantly increasing their risk of alcohol and drug addiction.

Body weight and iron levels are key factors linking depression to headaches, while physical activity provides indirect support.

Since only 38% find relief from standard depression treatments, diet is a vital add-on for reducing related inflammation and oxidative stress.

According to a study published in Microbiome, eating an orange a day may lower a person's risk of depression by 20%.

Longitudinal analysis suggests that the quality of our diet throughout our lifespan is linked with our cognitive abilities as we age

Speciality Food rounds up all the food and drink trends for 2026 you need to know

UCLA research shows that strong emotional connection can influence the brain-gut axis, dial down food cravings, and lower obesity.

Many of us will throw modesty out the window when it comes to Christmas lunch. But what do these blow-out festive meals do to our body and brain?

Increased selenium consumption correlates with lower suicidal ideation risk, according to a large population study.

Advocates criticize the Pentagon’s new, tougher fitness standards for emphasizing punishment instead of support for troops.

Research shows orthorexia nervosa prevalence varies but is consistently associated with perfectionism and obsessive-compulsive traits.

Manufacturers use deceptive marketing for desirability, so labeling UPFs as "products" rather than "foods" may offer consumers better clarity.

Impaired interoception may underlie mental health conditions like anxiety and eating disorders.

Dietary carbohydrate quality and quantity play a critical role in dementia development, according to a new multi-institute study.

A study of over 34,000 people has identified key characteristics of a healthy gut microbiome.

Parents report difficulty navigating weight and body image conversations with teens during the festive season.

A Swedish study is testing the MIND diet in adults with obesity to explore future links between nutrition, gut health, and mental health.

Research shows anxiety and insomnia lower natural killer cell counts, suggesting stress-driven immune suppression.
Stool molecules can accurately reflect diet and gut microbiome response, offering researchers a new tool to study nutrition's impact on health.

A six-month gluten-free diet eased disability and supported a healthier body composition in women with relapsing-remitting MS.

Sweet potatoes curb sweet cravings and provide other health benefits, along with dietary recommendations.

22% of GLP-1 users develop nutritional deficiencies, requiring dietitian support to manage side effects and prevent weight regain after stopping the drug.

New WHO guidelines recommend GLP-1 drugs for adults with obesity, urging increased manufacturing and improved affordability.

Experts worry that access to GLP-1 drugs is outpacing the scientific investigation into how these medications affect mental health.

Strong marriages may protect against obesity by influencing brain-gut communication, according to UCLA Health.

Lower choline levels in key brain regions are linked to anxiety disorders and intensified stress reactions.

Maternal eating disorders increase children's risk of asthma and wheezing, regardless of the disorder type.

Discover simple strategies to savor the year-end season mindfully without sacrificing your health.

College life encourages overeating in social settings and dining halls, with a study showing students underestimate their intake.

Drinking 3–5 cups of coffee daily may add five years to the life span of people with major psychiatric disorders.

The WHO now recommends GLP-1 drugs for adults with obesity and simultaneously calls for action on manufacturing and affordability.

Chronic fat-rich diets disrupt brain-gut chemistry, linking obesity, depression, and cognitive decline according to new study.

New research suggests that a moderate daily intake of unsalted peanuts improves brain blood flow and verbal memory retention in older adults.

Humans navigate the modern world with Paleolithic genes, increasing our susceptibility to several modern diseases.

82% of students believe poor nutrition is a greater campus problem than substance abuse, according to a recent poll.

UC San Diego researchers identified 11 genetic regions for impulsive choices (delay discounting) that overlap with genetic risks for obesity and diabetes.

An anti-inflammatory Mediterranean diet protects older women against early memory problems, showing diet's role in brain aging.

Research suggests that certain foods can help boost mood and increase long-term happiness, something to consider for your holiday feast.

New research links a balanced dietary intake of minerals like iron and selenium to a lower risk for common mental disorders.

Research shows that daily consumers of ultra-processed foods reported three times higher rates of mental distress (53% vs. 18%).

The joy and traditions of the holidays are often overshadowed by "food noise," or constant, intrusive thoughts about eating.

Ultra-processed foods now make up half of New Zealanders' diets, linked to health issues like diabetes, obesity, heart disease, and depression.

Prof. Mariana Chilton argues that when politicians politicize food benefits, the collective trauma is felt by the whole country, not just hungry families.

Flavonoid-rich foods (berries, citrus, cocoa) may improve mood and emotional resilience by supporting brain chemistry and neuroplasticity.

A comprehensive review of 50 studies on the ketogenic diet's mental health effects yielded mixed results that are both promising and inconclusive.

A diet low in glutamate significantly improved migraine symptoms for Veterans with Gulf War Illness, according to new university research.

Mukbang videos may reduce loneliness—a public health epidemic—by creating parasocial relationships and social interaction.

Explore the link between caffeine and anxiety symptoms, along with expert advice on moderating its impact while still enjoying coffee.

New obesity drugs are used off-label for slimness/social approval, interacting with stigma and inequality, requiring urgent intersectional research.

GLP-1 drugs aid weight loss but require psychological support to manage mixed mental health effects and risks of eating disorders.

Low omega-3 intake predicts increased ADHD severity in Palestinian adolescents, underscoring nutrition as a key intervention.

Parents often overlook early signs of an eating disorder, but it's crucial to trust your intuition and seek early intervention.

Among patients with moderate psychological symptoms, osteoarthritis, and obesity, diet and exercise were linked to improved mental well-being.

Regularly eating these foods is linked to chronic illnesses like obesity, type 2 diabetes, and heart disease.

Low levels of the essential nutrient choline are linked to anxiety disorders; increasing intake may help improve symptoms.

Experts discuss how commonly prescribed antidepressants, which are ingested orally, may alter the gut microbiome important for overall health.

UC Davis Health research shows people with anxiety disorders have 8% less of the essential nutrient choline in their brains.

Ultra-processed foods are rising in Mediterranean youth diets, linked to more screen time and modern lifestyles.

In IBS patients, higher intake of some Mediterranean foods increased symptoms, while a symptom-modified version improved gut microbiota.

Flavanols may boost brain function through their taste, which activates the nervous system and mimics exercise-like effects.

A new study shows that in families with autistic children, dietary differences—not gut microbes—are more closely tied to autism traits.

A new study found that multiple unhealthy habits—like poor diet, little exercise, and inadequate sleep—greatly increase the risk of depression.

When thoughts about food become constant or overwhelming—known as “food noise”—they turn ordinary eating decisions into mental fatigue.

A study found that fiber and high-quality carbs from whole foods in midlife boost healthy aging in women.

A U.S. study links food temperature to mental and gut health, with cold foods raising distress and hot drinks improving well-being.

New discoveries connecting diet and well-being are driving a modern medical shift that puts nutrition at the center of care.

A UCLA study links children’s early gut microbiome to later risk of depression and anxiety via emotion-related brain networks.

A new rat study shows exercise can ease mood effects of a high-fat, high-sugar diet, but healthy eating remains essential.

Losing SNAP benefits can harm mental health, as food insecurity and limited mental health support create a dangerous cycle.

Key points on integrated care: what it is, barriers to wider implementation, and why psychologists should get involved.

Fear of being judged for overeating can cause guilt, rigid eating rules, and difficulty engaging socially.

A new study found that eating more fruits and vegetables can improve sleep quality, with those meeting CDC guidelines seeing a 16% boost.

New guidelines promote a “Health at Every Size” approach for adolescent care.

A study by Başar Gökcen links night eating syndrome to food addiction, underscoring how eating patterns affect health and the value of mindful eating.

“‘Sugar feeds cancer’ is a dangerous claim,” says Stanford oncology dietitian Erika Connor, warning it fuels anxiety and misinformation.

Researchers show that voluntary running counteracts behavioral changes from a cafeteria diet through hormonal and gut microbiome pathways.

A 10-year study found SNAP benefits slow cognitive decline in older adults, adding several years of healthier brain aging.

A new study finds that gut bacteria may influence anxiety by affecting neuronal activity in the brain’s fear centers.

Over half of Americans’ calories come from ultraprocessed foods tied to disease, and experts urge cutting back by checking ingredient labels.

A major review finds diet may strongly impact pelvic floor health, suggesting nutrition could help improve sexual function and incontinence.

A UK Biobank study suggests that processed meat alternatives—popular among plant-based eaters—may not be as healthy as they appear.

A new study found that drinking even one or two sodas a day may disrupt gut health and raise depression risk by 16% in women.

A Journal of Eating Disorders study highlights how black-and-white thinking about food can shape eating behaviors and contribute to disordered eating.

A JAMA Psychiatry study found a wearable device can reduce stress, cravings, and relapse in substance use disorders.

In young rats, a ketogenic diet protected against prenatal stress, supporting brain development and sociability.

Researchers found that even moderate soda consumption may alter gut microbes and raise depression risk, especially in women.

New research shows that parents’ comments about weight impact children’s body image more deeply and lastingly than their own dieting behaviors.

A new study found that diets high in ultra-processed foods may worsen disease activity in people with early MS.

A study of 45,000 people found that eating plenty of fruits and vegetables is linked to lower psychological distress.

Researchers warn ultraprocessed food has lasting effects on older Americans, especially women, linking it to poorer health.

A new study finds that preschool girls who overeat regularly are more likely to show anxiety, impulsivity, and hyperactivity in adolescence.

Exposed early to foods high in fat, salt, and sugar, many older adults now meet criteria for ultra-processed food addiction.

An NYU study links higher midlife intake of ultra-processed foods to more cognitive complaints later in life.

Coffee and tea are two standout drinks for supporting brain health.

Research suggests that foods like fish and vegetables may boost happiness and life satisfaction, linking diet to better mental well-being.

A German study shows sugary drinks can harm both metabolic and mental health—especially in women—likely via the gut microbiome.

Young men who ate Greek yogurt post-workout had lower inflammation than those given carb pudding, suggesting fermented dairy aids recovery.

To lower dementia risk, experts recommend the MIND diet, exercise, and social engagement.

An animal study reveals how a high-fat diet disrupts neural circuits, offering a mechanism linking metabolic syndrome to memory deficits.

A new study links higher dietary creatine intake to better mental health, while lower intake was tied to greater depression, anxiety, and suicidal thoughts.

A WHO report says investing $3 per person yearly in noncommunicable diseases and mental health could save millions of lives and yield $1 trillion by 2030.

A new study shows that maternal diet and supplements during pregnancy can affect children’s brain development and risk of ADHD or autism traits.

An innovative Culinary Medicine model helps patients adopt healthier lifestyles by combining food counseling with cooking skills training.

GLP-1 drugs like Ozempic work best for diabetes patients who overeat due to food cues, but less so for those who eat for emotional reasons.

Keto diets and fasting show potential benefits for cognition and depression.

A UK study shows that a nutrient-rich diet can boost happiness and purpose in later life, but its impact is shaped by mood, health, and wealth.

A study finds that following a green-Mediterranean diet, including green tea and the aquatic plant Mankai, is linked to slower brain aging.

A study suggests that a well-formulated ketogenic diet may be a feasible adjunct to mental health therapy.

Researchers identified seven blood molecules linked to excessive daytime sleepiness, including those related to diet and hormones.

Eating a nutritious diet and timing meals—especially breakfast—may influence longevity.

Postpartum recovery is demanding, and depression can complicate it further. Emerging research asks whether diet may also reduce the risk of baby blues.

High consumption of artificial sweeteners is linked to faster memory and thinking decline, especially in younger adults and those with diabetes.

A new study shows 63% of people with ADHD regularly skip meals—often weekly, sometimes daily.

A new study finds that high consumption of certain artificial sweeteners is linked to significant declines in memory and word recall.

US study finds Mediterranean diet may lower Alzheimer's risk, even in those genetically predisposed.

New Cell Metabolism study: Highly processed foods, not just calories, harm health.

New research shows that a modified Mediterranean diet may ease menopause, reducing hot flashes and sexual discomfort.

CSIRO study links weight loss with better wellbeing and lifestyle.

Recent research highlights a strong link between nutrition and mental health in elderly nursing home residents.

A single high-fat meal can reduce brain blood flow within hours, raising concerns about stroke, dementia, and everyday diet impacts.

A new study found that a Mediterranean diet may reduce the risk of dementia and slow cognitive decline.

Research shows that childhood financial hardship and low parental education raise the risk of adolescent disordered eating.

New evidence suggests childhood eating habits can shape adolescent mental health, emphasizing the role of early diet.

A study finds ultra-processed foods harm weight, metabolism, and sperm quality, even without overeating.

A new study found that better sleep, diet, and activity boost young adults’ mental wellbeing—while fruits and vegetables may even buffer poor sleep.

Healthy diets may support brain aging, but stronger results come when combined with exercise, cognitive training, and vascular health.

A ketogenic diet may reduce fatigue, improve neurological function, and enhance quality of life in people with multiple sclerosis (MS).

Genetic analysis shows insomnia and gut microbes influence each other, explaining their frequent link.

Researchers have identified seven blood molecules associated with excessive daytime sleepiness, including factors linked to diet and hormones.

A multinational study of over 400,000 people found that a plant-based diet is associated with a lower risk of multiple cancers and cardiometabolic diseases

Social media amplifies performative eating, with platforms flooded with aesthetic food content and viral “what I eat in a day” videos.

A Frontiers in Nutrition study examined Mediterranean lifestyle habits and their gender-specific links to health and behavior.

New study suggests links between gut microbes and mental health may open the door to large-scale probiotic trials.

New research finds that adding red meat to high-quality diets supports key nutrients for mental health and improves gut microbial diversity.

Scientists uncover how mineral-rich diets may help protect mental health across cultures.

The Lancet Psychiatry Commission urges greater investment in lifestyle interventions to reduce the 15-year life expectancy gap in people with mental illness.

A study reveals that kids who display prosocial behavior are more likely to consume fruit and vegetables as teenagers

An unhappy gut can significantly impact both your mental and emotional health

Research uncovers gender-based patterns in Mediterranean diet habits and lifestyles

A recent large study untangles connections between weight, diet, and exercise.

New research reveals how impulsive personality traits steer food choices and alter the gut microbiome.

There has been a significant increase in disorders of gut-brain interaction, including irritable bowel syndrome, following the pandemic.

More people with Multiple Sclerosis are turning to diet changes for symptom relief, but research on their impact remains limited, a review found.

Men and individuals who are overweight may be particularly susceptible to the adverse effects of restrictive eating.

Many U.S. consumers are aware of the health risks of ultra-processed foods but still struggle to identify them or link them to diseases like type 2 diabetes.

A psychiatrist warns that marketing unhealthy foods to children is exploiting them and harming their mental health.

Individuals with long COVID face significantly higher rates of gut-brain interaction disorders, alongside worse mental health and quality of life

You may have a gluten intolerance if you get sick after eating gluten, a type of protein. You might feel tired, nauseous or bloated

Confusion over “healthy” ultra‑processed labels is misleading consumers and risks harming trust and public health

Researchers examined impacts of consuming ultra-processed foods (UPFs) on brain function and development

Mice were eating more because their brains were being tricked into feeling the desire for sugar just by watching someone else have a good time

Could a disrupted gut be fueling eating disorders? This study explains the gut-brain hormone loop behind anorexia, binge eating, and more

Social determinants play a role in the development of poor mental health, and food insecurity has been associated with increased anxiety and depression

There has been a tug-of-war in the debate of whether the main cause of obesity is diet or a lack of exercise

Psychiatrist issued warning that children are being exploited by the marketing of unhealthy foods, with serious mental health consequence

A Stanford dietitian explains what ultra-processed means, why it's unhealthy, and how to eat well despite it

We think we eat comfort food for pleasure, but science shows boredom and the need for a mental boost are the real drivers

Commercial baby foods often contain too much sugar and lack diversity, raising concerns as parents trust packaging over public health advice

Adding okra to the diet can protect against long-term metabolic problems caused by early-life overfeeding

Mediterranean diet may aid weight loss but doesn’t always improve brain health in aging populations

Exercise is a good way to boost mental health, but a recent study suggests that it's not just physical movement that affects mental health

Brief exposure to stress is associated with a rapid reduction of beneficial compounds produced by gut bacteria

This dietary approach may also enhance brain function in people without cognitive impairment

Scientists find lactose intolerance may link consuming dairy, bad dreams, and poor sleep

Drinking water can be just as good for mental and physical health

Psychologists are helping patients manage body image, identity, and relationship changes

Children whose diets more closely resembled the MIND diet performed better on a cognitive task measuring attentional control

From insects to plants: exploring the future of sustainable protein choices

Skipping breakfast is common among adolescents and is linked to poor adherence to the Mediterranean diet and unhealthy lifestyle factors

fMRI shows two brain areas activate together when feeling mentally tired, helping the brain decide to quit or keep going

Multimodal obesity care with GLP-1RAs must include diet, exercise, and lifestyle modifications

MIND diet may lower risk of Alzheimer's disease at any age

Research in mice reveals a link between obesity and anxiety, potentially driven by changes in brain function and gut bacteria

Rising grocery prices are forcing most Americans to shift toward ultraprocessed foods, leading to increased health risks

New research links calorie-cutting diets to increased depressive symptoms, especially in men and those overweight

A major study finds that workers who stick to traditional or modernized Japanese diets report fewer symptoms of depression

A review of 108 studies found strong global evidence that youth exposure to unhealthy food marketing across media promotes poor diets and health issues

A new study found a compelling link between the composition of the gut microbiome and the risk of cognitive impairment (RCI) in adults

According to the U.S. Department of Agriculture, 13.5% of American households experienced food insecurity at some time during 2023

A recent study by Harvard scientists confirmed that eating an orange a day may prevent depression

As the old saying goes, you are what you eat, so our diets play a tremendous role in how we feel from day to day

If you have an aversion to the bitter taste of grapefruit, cabbage, broccoli and even alcohol, you might be a "super-taster," and you're not alone

A new study reveals that lower diversity of microbes in the mouth is associated with greater symptoms of depression

Up to 67 % of female college students in the United States are battling some form of eating disorder

A low-energy diet like the NHS remission plan improved eating disorder symptoms in people with type 2 diabetes and excess weight

A new study has found a link between consuming more berries and healthier aging

Vegan diets are on the rise—but a growing body of research raises unexpected questions about their impact on mental health

Being mindful while eating is a key factor in choosing healthier, plant-focused diets, offering fresh insights for improving public health and sustainability

A large study in the Netherlands has found that inflammation is consistently linked to symptoms of depression and anxiety

A study of older individuals in Australia found that diet influences the relationship between depressive symptoms and Alzheimer’s disease biomarkers

Research finds that the key to improving health won’t necessarily be found in a pill, but in the foods we can choose to eat every day

Going too far with a diet might have impacts on your mental health. Cutting your calories down too far could be linked with depression symptoms

Poor nutrition isn’t just bad for your health—it’s draining your energy, mood, and motivation

Adopting the MIND diet—even later in life—is linked with reduced dementia risk

With obesity and anxiety rising—especially in young Americans—new research links the two through gut-brain interactions

New research shows biomarkers could provide insights into how ultraprocessed foods impact the body

Colleen Sloan, PA-C, RDN, highlights the connection between poor dietary patterns and mental health challenges in children

Ultra-processed food diets linked to higher stroke + cognitive impairment risk regardless of diet quality

New obesity models aim for precise, respectful, and person-centered approaches

New evidence suggests your favorite convenience foods could be affecting your mental health

In a small college migraine cohort, anxiety and depression scores improved with better elimination diet adherence

Older Australians who eat a diet high in ultra-processed foods have an increased risk of depression, new research has found

Mass General Brigham researchers created a public database on processed food availability, highlighting the need for better regulation

The population faces a deep food crisis with limited access, poor diets, collapsed services, and greater impact on vulnerable groups

Vegetarians reject meat with disgust, mirroring the strong aversion meat-eaters feel toward taboo foods like human flesh or feces

ARFID is an eating disorder marked by extreme food avoidance, often due to sensory issues or fear, leading to nutritional and social challenges

Prediabetes poses mental health risks too—early intervention is key to protecting both body and mind

The FDA and NIH launched a joint initiative to support Health Secretary Kennedy’s Make America Healthy Again plan

People who eat more ultra-processed foods are more likely to have early signs of Parkinson's disease when compared to those who eat very few

About half say healthiness of food is important when deciding what to eat. But taste and cost matter more

The "rest and digest" system is crucial for well-being, yet is often an overlooked aspect of mental health

Western-style diet rich in processed foods disrupts the gut microbiome’s ability to recover after antibiotic treatment

Study finds diets high in ultra-processed foods harm mental health and identifies biological markers explaining the link

Researchers assessed the associations of ultra-processed foods (UPFs) and related metabolic signatures with mental disorders

Higher intakes of black tea, berries, citrus fruits and apples could help to promote healthy aging, new research has found

HHS Secretary Robert F. Kennedy, Jr. recently compared sugar to poison

Daily meals play a pivotal role in shaping physical health and mental well-being, influencing our overall quality of life

Foods that showed the highest association with healthy aging are fruits, whole grains, and vegetables

Adults with severe mental illness reported obesity in 42% of participants, along with poor diet quality and ineffective weight management

Mindfulness-Oriented Recovery Enhancement (MORE) can rewire the brain to boost mood, enhance positivity, and reduce cravings

Health behavior refers to the actions, beliefs, and habits a person follows related to maintaining, restoring, and improving their health

New study finds that individuals with childhood ADHD are more likely to consume fast food frequently in early adulthood

Research links high-fructose diets, especially from processed foods, to disrupted appetite signals and long-term brain changes

Researchers find gut microbial markers in depressed older adults, suggesting new personalized mental health treatments

Older adults who eat more organic food tend to have better cognitive performance, according to a new study

Study highlights the link between food and cognitive decline, at a time when more than 7million people in the US are affected by dementia

Over 1 in 5 boys and men in Canada and the U.S. may have an eating disorder, highlighting the need for better awareness and support

New study highlights how cultural and family influences shape body image and eating behaviors in young women

The odds of migraines, abdominal pain, and body pain are increased in women with poor oral health according to recent study

Lifestyle medicine and mental health management in pediatric primary care promote positive health and holistic well-being

Vagus nerve, which helps regulate appetite, interacts with socio-economic status to influence eating behavior

Evidence linking gut health to sleep apnea, suggesting changes in gut microbiota influence the severity of sleep-disordered breathing

Research initiative is investigating how obesity reshapes brain circuits involved in potentially driving unhealthy food decisions

Intermittent fasting may boost cognitive function and brain health, with potential for neurodegenerative disease research

A new network is working to transform healthcare by making nutritious food a key part of treatment and disease prevention

People who regularly share meals with others tend to be happier and more emotionally satisfied, regardless of age, culture, or background

Inconsistent food access, mental and physical health, and binge eating–promoting narratives all impact binge eating behavior

Sustained social engagement—especially through varied activities—is linked to healthier eating

Probiotics may lift negative emotions in healthy people, opening new avenues for preventive mental health strategies

Eating more ultra-processed foods may be associated with structural changes in brain regions involved in regulating food intake and reward

Why individuals acclimated to high-fat food begin to devalue it—get less pleasure from it—yet continue to eat it and become obese

Vitamin K deficiency may harm brain health, causing inflammation and fewer new neurons in the hippocampus, impacting memory

Swapping soda for black coffee could benefit mental health, as new research links sweetened drinks to poorer outcomes

Researchers uncover how emotional eating and body image shape our health—new insight for obesity and mental health strategies

New evidence reveals treating SIBO with antibiotics, diet, and supplements dramatically boosts quality of life

Large study finds different types of beverages linked to likelihood of developing depression and anxiety disorders

Can changing your diet in your 40s protect your brain? New study shows MIND diet lifts mood and lifestyle before cognitive decline begins

Study finds diets high in ultra-processed foods erode mental wellbeing—boosting depression risk and undermining quality of life

Beneath UPF's convenience lies a growing body of evidence linking them to rising rates of depression, anxiety, and cognitive decline

Major study finds vegetarian diets could reduce chances of aging healthily—unless adults eat high-quality plant-based foods

Study finds high-salt diet in mice induces depression-like symptoms by increasing IL-17A linked to human depression

Most comprehensive global analysis estimates overweight/obesity rates more than doubled over past three decades

Maternal diet during pregnancy may be associated with a higher risk for mental health disorders in offspring

Brain scans of obese individuals show reduced activity in pleasure-related brain regions when presented with food

Percentage of teens eating healthy, exercising regularly and getting at least eight hours of sleep was lower in 2023 than in 2013

Researchers interviewed 45 young people about how their environment and social life influence their food choices

Fermented foods like yogurt, kimchi, and miso may reduce anxiety and depression by impacting gut bacteria and brain chemistry

Obesity rates are set to skyrocket, with 1 in 6 children and adolescents worldwide forecast to be obese by 2050

More than half of 23-year-olds in a European study show restrictive, emotional or uncontrolled eating behaviors

Older adults who eat fewer fruits and vegetables face higher chance of injurious falls

New study explores how kefir reduces neuroinflammation and supports brain health/Alzheimer's

Experts are interested in how the gut microbiota may influence mental health conditions like anxiety

Mothers suffering from postpartum depression can affect children's capacity for self-regulation

People who have a lower WHR during midlife may have better brain and cognitive health in older age

People who consume high amounts of UPFs have increased risk of anxiety, depression, obesity...

Microbiome imbalances may contribute to anxiety disorders—probiotics might help

Children who regularly eat seafood at age 7 exhibit more positive social behaviors by ages 7 and 9

Most dietary programs make no mention of ultra-processed foods (UPFs)

Students who often eat takeaway and exercise little have a higher risk of depression and anxiety

How does our food supply interplay with consumption choices and regulations?

A high-fat, high-sugar Western-style diet quickly reduces brain blood flow in adolescent mice, but adding omega-3s from fish oil can reverse this effect.

Can we self-regulate our eating behavior, or are we tied to a shot forever?

New study reveals that consuming high-calorie, highly processed foods for just five days can reduce the brain’s sensitivity to insulin

A large study found that Western diet during pregnancy associated with increased risk of ADHD and autism

Recipe4Health is part of a therapeutic approach called "Food as Medicine," which holds nutritional interventions

A new study shows that just three days of a high-fat diet can cause memory impairments and brain inflammation in older adults

Ultra-processed foods trigger inflammation and disrupt gut bacteria, potentially driving diabetes, cancer, and neurological diseases

Researchers designed intervention to target problematic aspects of UPFs, including being engineered to be addictive

Study helps guide Hispanic/Latino individuals toward consuming Mediterranean diet without altering established diet

Emerging evidence suggests that lycopene-a natural plant extract-may have antidepressant properties

New resesarch suggests that microbial metabolites– specifically indoles–play a direct role in regulating brain activity linked to anxiety

New research shows diet could influence risk of both depression and Alzheimer's

First clinical trial examining Ketogenic Diet’s effects on bipolar disorder in adolescents

Researchers discover that although patients with depression generally have less appetite, they prefer carbohydrate-rich foods

Poor nutrition threatens operational effectiveness. Performance and resilience hinge on strategy, technology, and the quality of diet

Study identified metabolite in gut microbiome that helps regulate brain activity linked to anxiety

How menopause impacts eating habits and mental health

Experts reveal how mental health and societal influences play a crucial role in tackling obesity.

Can you treat eating disorders with a microbiome-friendly diet?

Chili peppers may influence ADHD symptoms through gut-brain connections

New study shows how intestinal microbiome modulates influence of citrus on mental health

Carbohydrate cravings related to severity of depression and anxiety symptoms

Pilot Study to Explore Ketogenic Diet Combined with Mood Stabilizing Medications

Sugar has addictive potential, yet it is deeply embedded within our food supply.

Study provides new insights into how exercise can aid appetite control and weight management.

Replicating meaty flavor and a sensation of richness could encourage more plant-based eating, according to new study.

Study finds ‘good’ bacteria was more plentiful among children with earlier bedtimes compared to those who fall asleep later.

Study: children experiencing at least one traumatic event had 50% more risk of being obese by 8. Conversly, positive experiences can prevent risk.

Research shows a link, not explanation for why switching toolive oil could lower the risk of dying from dementia by 8 to 14%.

Researchers found that new habits can begin forming within two months but can also take up to a year to stick.

Researchers link pre-surgery exercise and nutritional enhancement to better outcomes, shorter hospitalization.

By 2027, this common food dye, linked to cancer in non-humans and behavioral issues in children, must be removed from foods and medicine.

Professors are pioneering a personalized approach to treating depression treat by exploring how brains process rewards and setbacks.

Study highlights the potential protective role of fruit and vegetable consumption against depression.

Researchers identified distinct neurons responsive to sugars or fats, which may lead to breakthrough obesity treatments.

Study: people who eat processed red meat have a greater risk of developing cognitive decline and dementia than those who eat little to no red meat.

Growing research strengthens link between the gut microbiome and mental disorders, such as treatment-resistant schizophrenia.

Research has identified, for the first time, the brain's food-specific memory system and its role in overeating and diet-induced obesity.

Research suggests structural differences in the brain contribute to the development of disordered eating in young adults.

Inhibitory control often subsides during adolescence; however, can be perpetuated by an individual’s diet.

New study suggests risk of developing dementia after age 55 among Americans is 42%, more than double previous studies suggest.

Decreased expression of free fatty acids in mice and diabetic patients linked to higher sugar intakes.

Study suggests that diet during adolescence can have long-lasting effects on behavior and neurobiology.

Study suggests that Mediterranean diet changed gut microbiota and improved lipid levels, and improved memory and cognition.

Researchers find 'brain maturation' process is factor in teens developing restrictive and emotional/uncontrolled eating behaviors later on.

Fatty acid in Camembert, enhances cognitive function, offering potential insights into combating cognitive decline.

Researchers find food quality and diversity have bigger impact on the structure of the gut microbiome rather than type of diet.

Approximately 80% of the modern workforce may experience higher risk of insomnia because of sedentary jobs.

Bacterial changes from following a Mediterranean diet correlated with better memory and cognitive performance.

Study confirms diet quality holds the secret to managing depression.

Food is medicine (FIM) movement has interest and investment from stakeholders, including government agencies, healthcare and charities.

More research bolsters link between diet, blood sugar control, and brain health in aging adults.

The psychology behind the office candy jar, including the risk-reward reasoning behind asking for a piece.

Researchers are finding promising — and surprising — ways to boost our brain health and de-stress our minds.

Holiday season often involves changes in diet, increased stress and anxiety, disrupting even the healthiest digestive systems.

Research found that teens with ADHD tend to consume more snacks than their peers without this disorder, however, impulsivity also plays role.

Eye-tracking study suggests people choose festive, sugar-rich foods versus healthier choice during indulgent holiday season.

Targeting enzyme in specific brain regions may lead to novel therapies for obesity and metabolic disorders.

A higher-quality diet, rich in whole, nutrient-dense foods, may contribute to reduced pain levels, particularly among women.

Data revealed that each additional fast-food meal per week was associated with a 4% higher likelihood of depression.

A previously unknown population of neurons in the hypothalamus may pave the way for new obesity treatments.

Study sees improved cognitive function with probiotic supplements and prebiotic-rich diet.

Growing research shows a healthy, anti-inflammatory diet may prevent and even improve mental health.

Chronic health conditions and food set to take a big role in potential policy changes in 2025.

Study shows positive correlation between a plant-based diet and better sleep.

Diet emerging as significant factor in anxiety and depression symptoms.

Additional oversight needed to connect mental health and physical health.

Sedentary nature of truck driving, reduced physical activity, access to nutritious food, and irregular sleep schedules, has impacted driver health.

Children taking the micronutrients showed significantly reduced symptoms compared to those in the waitlist control group.

High intake of both fruit and vegetables associated with lower depressive symptoms over time compared to a low intake.

New study finds eating more vegetables, fruits, grains, lean proteins, and dairy was linked to less pain, especially among women, regardless of body weight.

Added sugar in diet can speed up epigenetic aging, while a sustained, healthy diet with can slow it down and possibly reverse biological aging.

Research unveils a previously unknown pathway from gut to brain which may be contributor to the onset of Alzheimer's disease.

Substantial insurance savings associated with weight loss for adults.

Chronic inflammation is convincingly linked to higher risk of psychiatric disorders.

Now, a new study finds people who have a habit of eating a little dark chocolate per day have a 21% lower risk of developing Type 2 diabetes

To optimize your gut health, try adding these probiotic foods to your diet.

Obesity has become an epidemic that affects some states more than others

Obesity may alter the brain's reward system and affect the enjoyment of activities

Survey reveals 85% of consumers say a healthier diet is important to support their mental and physical health

Researchers show interest in how diet and the microbiome influence the development and progression of the condition

Although mental health disorders and the gut might appear unrelated, scientific studies have demonstrated a strong connection between them.

People who consumed fruit more frequently experienced less depression and improved mental well-being.

Could food be the future of mental health care?

Over time, dining out can take a health toll. How much is too much?

New research has found that a flavanol-rich cocoa drink can protect the body's vasculature against stress even after eating high-fat food

“Food noise” mind chatter interferes with the ability to make healthy choices and increases stress and anxiety around eating

The United States ranks 13th in worldwide obesity rates according to the WHO, while European countries rank much lower

The industry must play a role in this essential initiative to safeguard the health of Americans.

Discover what daily strategies can help reduce the constant thinking of food.

Are attempts to avoid the freshmen 15 doing more harm than good?

New research examines the impact of ultra-processed food, screen time, and maternal education on weight and well-being in adolescents

Military's reliance on fatty and packaged foods could be leading to sub-par performance and mental health problems

Mediterranean diets significantly slowed age-related brain shrinkage by about 50% over 18 months

High consumption of ultra-processed foods is associated with the acceleration of biological aging

Mediterranean and green-MED diets rich in polyphenols may slow brain aging and reduce neurodegeneration

Study uncovers role of gut microbiota in regulating stress responses through circadian rhythms

Feeling stressed can often lead people to reach for a high-calorie, sugary comfort food.

Keto diet might be able to calm an overactive immune system and diseases like MS

Insufficient magnesium and calcium levels may speed up cognitive decline in older adults

Researchers have uncovered how the ketogenic diet may help treat autoimmune disorders through a newly discovered gut-brain connection.

A small clinical trial led by Stanford Medicine found that the metabolic effects of a ketogenic diet may help stabilize the brain.

research is showing that the gut microbiome – the bacteria living in our digestive tracts – and the energy-producing compartments of cells, the mitochondria, remain hungry for nutrients missing in the American diet

New research finds that a low-sugar diet in utero and in the first two years of life can significantly reduce the risk of chronic diseases in adulthood.

Constipation and other gastrointestinal (GI) issues are common among autistic people. What's the link?

New research finds a link between higher omega-3 fatty acid intake and improved cognitive abilities in older adults.

Discover how loss of smell impacts breathing patterns and mental health, revealing the critical role our olfactory senses play in well-being.

Scientists have discovered a three-neuron pathway that connects a hormone responsible for signaling hunger to the chewing movements of the jaw.

Malnutrition, especially a lack of zinc, significantly impacts anorexia nervosa by influencing neurochemistry and mental health.

Scientists have found that your food choices are connected not only to physical and mental health but also to cognitive function, brain structure, and genetics.

Recent studies indicate that people with a "sweet tooth" may face a higher risk of developing conditions like type 2 diabetes and depression.

Stress might be the primary factor shortening lifespan, even when a healthy lifestyle is maintained.

This innovative tool motivates policymakers to tackle the real-world challenges that individuals encounter in their everyday food habits.

Metabolic or Nutritional Psychiatry, a growing psychiatric subspecialty, focuses on addressing metabolic dysfunction to improve mental health.

People with a preference for sweets are at a higher risk of developing depression, diabetes, and suffering a stroke.

Discover how mapping individual gut microbiomes could lead to personalized dietary recommendations for better health.

Does the psychobiotic diet, aimed at maintaining a healthy gut microbiome, work for reducing anxiety?

Research finds that time-restricted eating may help improve glucose control and weight loss among adults with metabolic syndrome.

A new study reveals that many Americans are eating diets that increase their risk of inflammation, leading to major health issues.

Some research suggests certain foods may help boost levels of serotonin, known as the ‘feel-good’ chemical. Is this true?

Does color change the experience of food?

Recent research uggests that eating fish may help protect against cognitive decline, dementia, and Alzheimer’s disease.

Sticking to the MIND diet for 10 years produced a small but significant decrease in the risk of developing thinking, concentration and memory problems, a recent study found.

Illness could be treated as a physical, rather than mood, disorder, according to scientists in Edinburgh.

New research reveals that eating colorful fruits and vegetables helps lower the risk of frailty in adults, promoting strength and vitality with age.

Early life in low-food access areas linked to higher childhood obesity risk.

Ultraprocessed foods on the rise: A growing threat to global health.

Neurons in sync: How the brain regulates food intake for balanced energy.

Are today's weight loss medications steering us away from sustainable health solutions?

Discover why this panel is encouraging local food traditions, particularly traditional fermented foods, as a way to combat the increase in unhealthy eating habits.

Learn how to prioritize your health even if you live in a food desert.

Discover the relationship between iron deficiency and sleep-related disorders.

Is the food experience in prison a punishment in itself?

Discover what science actually says about sugar.

Discover these new evidence-based recommendations on urgent public health issues.

Discover why we crave junk food and how to develop healthier habits.

Recent research reveals that a surprising percentage of adults age 50 to 80 show signs of addiction to highly processed foods.

Scientists have gained fresh understanding of how the brain regulates eating habits, potentially offering breakthroughs in addressing obesity.

Explore the negative impacts of a high-fat diet and its connection to obesity.

New research shows that those who spend time in nature have an increase in happiness and a decrease in anxiety.

A recent study discusses the potential of lingonberry juice for alleviating inflammatory bowel disease.

New research finds that those who no longer meet the diagnostic criteria for PTSD have a reduced risk of type 2 diabetes.

Explore how menu calorie labeling might intensify symptoms in individuals with eating disorders.

A 2020 review found that food insecurity was linked to an increased prevalence of behaviors associated with eating disorders in adults.

Study highlights significant need for support due to high anxiety levels in food allergy sufferers

Discover the link between your gut microbiota and how effectively you manage stress.

Discover the link between unhealthy commodities and mental health.

Recent research discusses the role of both diet and gut microbiota on cognition and well-being.

Discover the link between diabetes and mental disorders.

Turns out eggs may help maintain cognitive function, especially for women.

Research shows that diet can greatly impact the risk of depression and anxiety.

New research shows that those who follow a nutrient-dense diet are less likely to have anxiety disorders.

The cumulative impact of eating disorders has been significantly neglected and insufficiently studied.

Discover how an anti-inflammatory diet can help reduce stress, improve your sleep, heal your gut, and more.

New research shares how a gluten-free diet may help those who suffer with their mental health.

New research highlights the role of gut microbiota in type 2 diabetes mellitus.

Discover how stress impacts the brain's reward system and the way we eat.

Discover the benefits of a produce prescription program being piloted at Horizon House in Wilmington.

A new study from the University of Hyderabad suggests that a vegetarian diet may improve mood and cognitive function.

A new study from Singapore suggests that eating more fruit in midlife could reduce the risk of depression in later years.

Recent research found that stress-sensitive neural circuits affect the gut microbiome by directly influencing duodenal glands.

Could following a Mediterranean diet reduce your stress levels? New research says yes.

Research shows that TikTok exposure harms mental health, especially when it comes to body image and disordered eating behavior.

Discover the various reasons why diagnosing an eating disorder in athletes can be tricky, especially for females.

Recent research reviews how the harmful impacts of a Western Diet are spreading worldwide.

Discover why high-fat, high-sugar food may lead to a substantial decrease in well-being.

Research suggests that consuming fish oil supplements in later years may lower the risk of Alzheimer’s disease for certain individuals.

Research finds that improving diet and incorporating more movement can be as impactful as seeing a psychologist.

A recent animal study shows that supplementing with coffee polyphenols can mitigate the effects of chronic stress.

Researchers have found a link between a diet without much added sugar, and having a younger biological age at the cellular level.

New research shows that dietary intervention may reduce inflammation and modify gut bacteria, aiding in the obesity problem.

Recent research finds that staying healthy and eating a nutrient-dense diet is associated with reduced anxiety levels in college students.

What triggers food cravings and wha can we do about them?

The WHO advises against using non-sugar sweeteners for managing body weight or lowering the risk of noncommunicable diseases.

Recent research discovers that mothers experience negative mental health impacts due to food insecurity.

New research finds an association between the Western diet and both inflammatory bowel disease (IBD) and colorectal cancer.

Following a Mediterranean diet more closely is linked to reduced chances of depression in people with rheumatoid arthritis.

New research shows high fruit consumption to be associated with lower odds of depressive symptoms during late-life.

New research shows that India's adult obesity rate has more than tripled, and the annual rise in childhood obesity is the steepest worldwide.

New research discovers the effects of daily vinegar ingestion on depression symptoms.

Discover how a high-fat, high-sugar diet alters neural pathways and influences food-seeking behaviors.

A recent study explores the impact of substantial weight loss in severely obese individuals.

Discover how airmen prioritize health and wellness.

Explore the rising popularity of fermented foods.

A new study suggests that a healthy prenatal diet may reduce the risk of autism and social communication difficulties in children.

A new study of airline personnel found that irregular meal times can increase the risk of anxiety and depression.

Discover how the frequency and quality of your stool may reveal a lot about your long-term health.

New research emphasizes the need for awareness and better support for athletes.

Study reveals iron deficiency in Swedish military women doubles during training.

A recent study examined how lifestyle habits and diet affect depression in people with diabetes.

Recent research examines the link between adherence to the EAT-Lancet diet and the occurrence of anxiety and depression.

Maintaining a high-quality diet during youth and middle age contributes to preserving brain health in later years.

New cooking classes for older people of color may delay diet-related diseases and offer numerous other benefits.

People with ADHD may be up to 18 times more likely to face an eating disorder than neurotypical people.

Gut bacteria linked to food addiction and obesity: Identifying triggers and safeguards.

Researchers have found that dietary fiber crucially influences the balance between beneficial and harmful substances by affecting colon bacteria behavior.

A recent study in Nature Mental Health explored how patterns in the brain-gut microbiome (BGM) are linked to stress resilience.

According to a major study, consuming ultra-processed foods significantly increases the risk of depression.

Discover the possible links between dietary intake and ADHD.

Discover how food insecurity and mental, emotional, and physical depravity are tied to food hoarding.

Discover the link between resiliency, the brain, and the gut microbiome.

New research shows that American's diet quality is improving, if only by a little.

Dive deep into the psychological effects that patients with GI disorders often experience with Dr. Madison Simons.

Recent research addresses the impact that diet and the gut microbiome have on PTSD symptoms.

Recent research reveals how the father's health can impact their children even before conception.

New research shows the connection between a high-fat diet and the expression of genes that are associated with stress and anxiety.

Ongoing research continues to uncover links between ultra-processed foods and various health issues.

Australian schools step in to feed their children, boosting their mental health and development.

Recent research links ultra-processed, plant-based food to an increased risk of cardiovascular disease and mortality.

New research finds that junk food may increase anxiety instead of providing comfort.

Eating a poor quality diet might lead to brain changes that are associated with depression and anxiety.

New research finds specific neurons that drive compulsive eating.

Do poor eating habits decrease gray matter and impact neurotransmitters in the brain?

A recent review analyzed traditional Latin American, Asian, and African diets and their impact on diet quality and health markers.

New research looks at fruits' contribution to well-being for individuals 45 and older.

New research shows that micronutrients may be an overlooked treatment for depression.

Intake of ultra-processed foods is associated with a higher prevalence of insomnia, according to a new study.

New research on fruit flies provides novel insights into overeating, obesity, and memory in humans.

While research has explored the mental health impact of Ozempic, less attention has been given to their effects on those not taking them.

New research shows that spending time in nature has an influence on our dietary intake.

Could supplementing with omega-3 fatty acids help reduce aggression?

Discover how nutrition impacts sleep.

Kimberly Wilson provides valuable insights into nutrition's role in improving mental health.

Discover valuable insights on improving our diet as a nation with doctor Chris van Tulleken.

Is distraction increasing your caloric intake?

New research sheds light on the beneficial impacts of a nutrient-dense diet on the brain.

This article explores the connection between Crohn's disease and the gut-brain axis.

Discover the connection between ADHD and hyperfixation meals.

Discover how your dietary intake influences your gut health.

Could a ketogenic diet be the key to improved mood and mental health?

Struggling with anxiety? Try sipping on these drinks recommended by dietitians.

New research shows that individuals with depression and anorexia have distinct differences in their gut microbiota composition.

Research shows how a high-fat diet leads to cognitive decline.

Discover the pervasiveness of weight stigma in the military.

Eating a handful of nuts every day is associated with a 17% lower risk of depression, scientists have said.

New research shows that there are three psychological reasons why people avoid going vegan.

New research suggesting that dietary interventions could help reduce the incidence and intensity of bipolar disorder.

A new study dives deep into the factors influencing adolescent's consumption of processed food and screen time.

New research finds that just seeing and smelling food may drive adaptations in the liver.

Discover why high-fat diets may contribute to the development of Alzheimer's disease.

New research sheds light on an omega-6 polyunsaturated fatty acid that is linked to a lower risk of bipolar disorder.

Discover what the current research says about food additives and mental disorders such as depression and anxiety.

New research reveals a strong relationship between diet and brain health, cognitive function, and well-being.

New research finds that following a ketogenic diet may have important inclinations for the progression of Alzheimer's disease.

'Ozempic Personality' suggests that individuals using GLP-1 drugs may experience changes in their mood and demeanor.

A recent study takes a look at the relationship between consuming a Mediterranean Diet, subjective well-being, and socioeconomic factors.

New research highlights how consuming green tea can boost mental performance.

In a recent animal study, researchers find that memory damage from a Western diet remains even after implementing a healthier diet approach.

Discover what the novel term, food noise, means and how to combat it.

New research shows how major food brands are leveraging the anti-diet movement for profit.

Do high blood-sugar and triglyceride levels predict depression and anxiety?

Could following a Mediterranean diet reduce your stress levels?

Discover the optimal diet for brain health.

New research takes a deep dive into the ability of psychobiotics to restore microbial balance and regulate the MGB axis.

New research discovers how obesity-related inflammation may impact cognitive processes.

New research takes a closer look at the relationships between depression, nutrition, exercise, and our gut microbiome.

How does loneliness impact control and motivation?

Discover the pathways underlying how greener environments improve psychological well-being.

New research finds that the metabolic effects of a ketogenic diet may help stabilize the brain.

Research increasingly links dietary patterns to cognitive health.

https://www.psychologytoday.com/ie/blog/addiction-outlook/202403/addicted-to-food?amp

Current research links anorexia to certain brain regions and paves the way for new therapies.

Discover the pervasive impacts of a high-fat, high-sugar diet.

New research sheds light on what cells may be responsible for food-seeking behaviors, regardless of hunger.

Could high-fat foods before surgery lead to less effective outcomes, leading to cognitive and memory deficits?

Discover the biological mechanism behind why diet can slow down the processes of aging and the development of dementia.

New research reveals that nutrition-related variables are significantly associated with the onset and progression of Alzheimer's disease.

Discover the new role of AI within the context of nutrition.

Discover how a low carb, high fat diet could be the answer to your mental health concerns.

New research finds that eating a high glycemic load breakfast could make you less attractive.

Discover how shifting one's diet may alleviate not only symptoms of IBS, but also comorbid depression.

Explore the profound effects that stereotypes surrounding eating disorders exert on individuals from diverse racial and ethnic backgrounds.

Following the Mediterranean diet is linked to a lower occurrence of depressive symptoms, specifically noticeable in women.

The prevalence of food insecurity on college campuses is an unforeseen yet escalating concern.

Discover the multiple ways through which loneliness, food, eating behaviors, and health outcomes are interrelated.

New research highlights how specific gut bacteria and short-chain fatty acids included in the Mediterranean and MIND diets improve cognition.

New research finds that a high-fiber diet may lead to improvements in memory and reductions in depression-like behavior in animal models.

Restaurant menus are crafted to encourage higher spending through strategic design tactics.

Discover the role of interoception in caring for your mind and body.

Is the Mediterranean Diet all it's cracked up to be? A psychiatrist weighs in.

What are the consequences of repeated exposure of junk food on social media?

Discover why adding berries to your diet could make you more resilient to stress.

Discover how oral health may predict well-being in older adults.

New research finds that a protein in wheat and other grains may worsen symptoms of multiple sclerosis.

New research adds to the evidence supporting a daily multivitamin for the prevention of cognitive decline.

Delve into the dynamics of yo-yo dieting and uncover the intricacies behind weight loss struggles.

New research takes a closer look at the associations between consuming a Mediterranean diet and symptoms of mental illnesses.

A new study shows just how fast eating kiwi can improve perceived health outcomes when compared to a vitamin C supplement.

Discover why the gut may be the mediating factor between fasting and its wide range of health outcomes.

New research divulges that we have two separate but consistent fat and sugar pathways that light up our dopamine reward centers.

The prevalence, risks, and consequences of eating disorders among individuals with rheumatic diseases require thorough exploration.

How does entering ketosis impact mental health outcomes?

A recent study proposes that addressing loneliness in individuals with obesity may contribute to extended and healthier lifespans.

Study suggests food choices can affect mental health over the long term.

Discover which foods help increase sleep quality.

Researchers discover separate brain pathways for fat and sugar cravings, revealing one reason we can't resist indulgent treats.

Discover the radical rethinking taking place when it comes to astronauts' diets.

Helping individuals discover the connection between their diet and mental well-being is paramount for the future.

Discover how negative expressions can influence desire of certain foods.

Flavonols, known for their antioxidant properties, have been linked to a slower decline in memory.

Discover how behavioral change psychology can help dental professionals when giving nutrition counseling.

Does someone you love have an eating disorder? Here's how to talk about it.

Research reveals correlation between varied diet and lower depression risk among knowledge-based professionals.

Do drugs such as Ozempic help with intrusive thoughts about food?

Scientists suggest that a study utilizing the transplantation of human microbes into mice could pave the way for potential therapeutic approaches.

Discover new links between diet-sourced microbiome metabolites and depression.

The gut microbiome plays a role in influencing stress-related reactions among individuals grappling with depression.

How has the pandemic impacted both mental and physical health?

Study suggests consuming fatty foods could impact brain blood flow in stressful situations.

What role could the ketogenic diet play in cognitive decline?

Excessive gas might signal a severe health issue.

Study findings suggest that following a vegetarian diet is associated with a reduced risk of experiencing insomnia.

Consuming comfort food due to stress can elevate the risks of both mental health issues and heart disease.

Could wasabi improve working and episodic memory?

Recent research finds that practicing mindfulness could help individuals better adhere to the DASH diet.

A new study finds that the Mediterranean diet leads to less severe disability for older adults with MS.

Late meals and snacks are linked to weight gain, acid reflux, and breast cancer.

The microbiota influences a wide range of human behaviors which impact our appetite and food preferences.

What are the pros and cons of social media in regards to our well-being?

Can medicine help food-related intrusive thoughts?

New research suggests that obesity may increase one's risk of cognitive decline.

New research reveals a molecule in the hypothalamus that plays a role in stress-induced eating.

Growing evidence suggests consuming healthy foods and micronutrients fosters better mental health.

Three dieticians weigh in on how nutrition plays a role in chronic pain.

Discover how a certain brain molecule, Proenkephalin, plays an important role in overeating after a stressful event.

New research discovers new insights around food preferences, particularly involving ultra-processed foods.

Could Lactobacillus be the key to preventing stress and warding off depression and anxiety?

Discover the newest research on the gut microbiome, microorganisms, and their role in overall health.

New research sheds light on the complex relationship between what we eat and the quality of our sleep.

Do the benefits outweigh the risks for those considering weight-loss drugs?

Is there a link between ultra-processed food and depression?

New research based on improved measures finds more substantial evidence that consuming a Mediterranean diet slows cognitive decline in older adults.

Discover which two personality traits are linked to vegetarian and vegan diets.

Discover what foods you can add to your diet to prevent or delay cognitive decline.
Discover the reasons why you may be cravings sweets and what to do about it.

Could strawberries be the key to thwarting off cognitive decline?

New research finds that a hunger hormone produced in the gut can directly impact decision-making and drive behavior.

New research finds that brain responses to nutrients differ in individuals who have obesity, even after they lose weight.

Discover how the Healthy Food Rx program helps those in a food desert manage their health conditions.

Discover how your brain and gut microbiome are intimately connected.

New research suggests limiting salt intake to lower blood pressure, even for those already on medicine.

New research shows that vegetarians tend to be more agreeable and more open to new experiences than those who eat meat.

Could a shift in dietary intake provide relief for those with multiple sclerosis?

What are the pros and cons to being a vegetarian athlete?

Discover why insulin resistance in the brain could heighten the risk of neurodegenerative diseases.

Discover the difference between processed foods and ultra-processed foods plus how these foods impact your health.

Discover how gut health may provide critical insights into AD prevention and management.

Could a mindfulness program help improve interoceptive awareness and adherence to the DASH diet?

New research looks at twins to discover how weight gain may be encoded in molecular processes of human cells.

Scientists examine the role of β-carotene in maintaining cognitive performance and mental health.

Check out this interview with Michelle Loy, MD, FAAP, as she explains her knowledge of culinary medicine.

Researchers found that middle-aged women on the DASH diet were 17% less likely to experience cognitive decline in their later years.

Felice Jacka speaks about the links between ultra-processed foods and our mental health.

The Food is Medicine Institute is ready to tackle the gap in the medical system between dietary intake and mental health.

Recent research shows how foods high in fat and sugar could be as addictive as smoking cigarettes.

Could the Mediterranean diet be the key to decreased PTSD symptoms?

Discover how your cognition directly reflects your dietary choices.

Could prebiotics lead the way for less invasive tactics towards eliminating obesity?

California takes initiative in removing food and drink additives that have been linked to health issues.

Could acknowledging food addiction lead to improved global health?

Discover the bidirectional relationship between food and sleep.

New research identified genes significantly associated with vegetarianism, primarily influencing lipid metabolism and brain function.

Discover the link between blood sugar imbalance and food insecurity.

Those who shop for groceries online are noticing more and more discrepancies between product's expected and actual nutritional value.

Discover the link between discrimination, food poor choices, and altered responses in the gut and brain.

What is the link between diet soda, specifically aspartame, and Autism?

What impact does Ramadan intermittent fasting have on the microbiome of the gut?

New research points to the critical need of making healthy food available to people in low income areas.

What are psychobiotics and how can they improve your health?

Does the microbiome shape the integrity of the brain-blood barrier?

Discover how the quality and quantity of your snacking habits impacts your overall health.

US study finds association between large amounts of ultra-processed food, especially artificial sweeteners, and depression.

Could the neighborhood you live in impact not only your food choices and weight gain but the structure of your brain as well?

What role does lifestyle play when it comes to depression?

New research highlights how socioeconomic vulnerabilities are associated with kids consuming more sugar-sweetened beverages.

A recent study determines whether the intake of non-sugar sweetened beverages impacts insulin.

Learn how a quality diet can impact the gut microbiota and therefore our brain health.

How does the food industry influence policymaking and how can we boost public health regardless?

New research highlights how microbes in the gut influence pain.

Could a prescription based-model help to decrease BMI, blood sugar, and blood pressure levels?

New research suggests that the more an individual's diet is composed of ultra-processed foods, the higher their risk of depression.

New research highlights how consuming ultra-processed foods may have long-lasting health impacts.

Discover the many ways that being hungry impacts our mood and behavior.

A recent study highlights how eating a Mediterranean diet impacts firefighters.

What influence does food environment have over consumer's choices?

A recent study investigates the associations between dietary patterns and mental health.

Can eating nuts support your mental health?

Discover why fermented foods are critical for supporting gut health.

Growing evidence suggests consuming healthy foods and micronutrients fosters better mental health, while poor-quality diets diminish it.

A recent review highlights the beneficial effects of oat consumption on gut microbiome function.

In a recent study, researchers share the results of a longitudinal analysis that highlights the link between sugar-sweetened carbonated beverages and depression.

Can you mitigate the impacts of stress with diet?

Nix the prebiotic sodas and focus on this nutrient instead.

New research questions whether the Western diet is linked to major depressive disorder.

SPH researchers found support for the “feast or famine” cycle hypothesis in food-insecure households.

Does inflammation in the brain shape how we respond to appetite and hunger?

Gain insight into the value of food and how it reaches beyond just nourishment.

Discover how Japan's culture leads to lower obesity rates.

Does the Mediterranean Diet prove beneficial for a population at greater risk of developing Alzheimer's?

New research highlights how a consistent sleep schedule is beneficial for our gut microbiome and overall health.

New research finds that consuming two servings of strawberries daily is linked to several benefits.

Discover how a more nutrient-dense diet benefits female athletes.

Are our dietary preferences a result of our genes? These researchers wanted to find out.

A study published in Nature Neuroscience sheds light on how the microbiome and autism interact.

New research finds the gene that produces a signal needed for the development and maintenance of the blood-brain barrier.

Esport athletes stand to improve their performance by improving their dietary intake and sleep habits.

New research highlights how the immune system communicates with the brain to warn about potential dangers in the environment.

Discover obesity's relationship to an array of mental health problems.

Discover what lead one scientist to study the connection between the gut and mental health.

Are soaring food prices taking a toll on people's mental health?

New research shows that a lack of reward response could lead to overeating and make it more difficult to change eating habits.

New research finds that a 14-strain probiotic blend could help support individuals with depression when used alongside antidepressants.

Recent research points to a reduced sensing of nutrients in the stomach and gut of those with obesity.

New research finds that consuming 60 grams of mixed nuts a day improves verbal memory and blood flow to the brain.

New research highlights the critical importance of a healthy diet, particularly during stressful periods.

Could shifting the focus of food-related policies and recommendations result in better mental health?

A new study shows that eating too much sugar can lead to inflammation in the gut.

New research demonstrates how flavanol consumption may impact memory function.

Research finds that a diet high in ultra-processed foods (UPFs) can increase the risk of depression by as much as 23 percent.

Discover the factors that shape our eating habits.

Can unhealthy eating habits established in college lead to future health issues?

New research finds that a daily nutritional supplement could enhance memory by the equivalent of three years.

New research reveals the increased risk of depression among individuals consuming over 30% of their daily diet from ultra-processed food.

New research explores food choices as they relate to the Big Five personality traits.

A new study sheds light on the potential role of diet in preventing dementia.

In a new study, researchers explore the hormonal, genetic, and neural pathways that regulate appetite and body weight.

Discover which diets and supplements may slow the progression of Alzheimer's Disease and improve cognitive function.

Science supports that the Dietary Guidelines for Americans (DGA) promotes a gut microbiota composition that may support overall health.

A recent study explores the effect of the DASH diet on mental well-being.

Does mental imagery activate similar neural networks to those linked with actual experience?

New research sheds light on the link between major depressive disorder, the gut microbiome, and the blood metabolome.

Could regulating fast-food advertisements have a beneficial health impact?

https://www.cnn.com/2023/04/24/health/fried-food-anxiety-depression-risk-wellness/index.html

Researchers utilized an animal model to investigate the impact on taste preference that generational exposure to a high-fat diet has.

Read these tips if you struggle with comparing your food intake to your partners.

New research shows how certain nutrients may increase synthesis of vital hormones that regulate sleep.

New research finds that men who identify as more masculine are less likely to reduce meat consumption or consider a plant-based diet.

Discover how sound and music impact our dietary intake among other eating related factors.

Researchers examined the impact that psychosocial stress experienced by the mother has on the gut microbiome of the infant.

Researchers use germ-free mice models to investigate the role of the oral-gut-brain axis in anxiety and depression.

What role does the food industry play in sugar addiction?

Consuming fermented foods can have a beneficial impact on both your gut and brain health.

Consuming excess sugar could led to poor health outcomes.

New research from UCLA may help tailor obesity interventions based on an individual's sex.

Many Americans believe that work, family stress, exercise, and social habits impact their mental health more than their dietary intake does.

These nine action-oriented tips may help your digestion, mood, and even disordered eating.

A recent study explores the dietary intake behavior and health of those who play video games.

Explore the links between the Mediterranean diet and mitochondria function.

A diet low in nutrients can negatively impact women's sexual health.

One study shows that higher levels of magnesium are associated with a 37% lower risk of developing dementia.

Researchers are working hard to pinpoint the beneficial nature of probiotics for cognitive decline and other health conditions.

Recent research points to evidence that dietary factors may directly affect the immune system, impacting inflammation.

Could psychobiotics be the answer to treating disorders such as anxiety and depression?

A new study shows how eating processed food may alter our brain activity and make us crave less nutrient-dense options.

New research identifies how a specific immune cell in the gut may impact stress-induced depression.

Could using probiotics to treat major depressive disorder be the personalized care individuals need?

The critical role of nutrition is gaining attention as a way to alleviate mood disorders.

Could gardening be your ticket to increased fiber and decreased anxiety?

Discover how what you digest impacts your mental well-being.

Those who follow the MIND or Mediterranean diet have fewer amyloid plaques.

New research shows link between eating ultra-processed food and depressive symptoms.

Scientists work on optimizing nutrition for astronauts headed deep into space.

Mental health and oral health impact each other in many ways.

New research sheds light on the link between irritable bowel syndrome and mental health.

Eating a healthy diet throughout early childhood leads to better mental health at eight years old.

A nutrient-dense diet can have a critical impact on the gut microbiota leading to improved overall health.

A new study highlights the benefits of nuts on cognition.

Researchers find that one in eight Americans aged 50 and older show signs of food cravings and addiction.

Researchers followed the course of glucose, leading to valuable insights regarding obesity and the brain.

Growing plants in space could support not only nutritional needs, but medical needs and crew psychology as well.

New research investigates whether changes in SCFAs and cytokine levels impact mental illness.

New research suggests that tree nuts may target serotonin and therefore reduce risk factors for cardiovascular disease.

A new poll points out that many older Americans have an unhealthy relationship with highly processed foods.

Should therapists rule out physiological imbalances before turning to psychotropic drugs?

A new study discovers that several types of bacteria are notably different in people with symptoms of depression.

New research shows how eating a high-calorie diet that is also high in fats could reduce the brain's ability to regulate caloric intake.

New research sheds light on the correlation between a highly inflammatory diet and an increased risk for depression.

Researchers argue the gut microbiome's importance when it comes to treating neurodegenerative diseases.

A new study reveals that a well-rounded dietary intake throughout pregnancy supports the child's neurodevelopment.

New research emerges on the relationships between loneliness, weight gain, and physical inactivity.

Recent research highlights just how connected our diets and psyches truly are.

Optimal nutrition is crucial during the first years of a child's life.

Improving executive functions could lead to better behavior management and health outcomes.

In this interview, Mary Beth Albright looks to nutritional psychology to examine the link between food and mood.

Could a lack of folate be responsible for rumination and worry?

Dr. Fiona Willer sheds light on why you should build a good relationship with food if you want to reach long-term goals.

Discover the links between what you eat, your physical health, and your well-being.

A new study suggests that those who do not consume meat experience more cases of depression.

New research sheds light on why some people may gain more weight than others, even when they eat the same.

Research finds that celebration increases health and well-being outcomes through perceived social support.

New research identifies a neuromarker for drug and food craving.

A new study sheds light on the reduced bacterial diversity found in patients with multiple sclerosis.

New research shows that students may want to up their walnut intake in the weeks leading up to an exam.

New research explores the benefits of a nutrient-dense diet for astronauts in response to negative health changes.

New research suggests that flavonols are associated with slower cognitive decline.

Support your gut health for better mental health.

Those who are hypersensitive to food allergens may experience changes in both their brain and behavior.

New research evaluates the Mediterranean Diet's link to healthy cognitive functioning.

Research finds that herbs and spices may impact the composition of the gut microbiome.

Could a lack of certain gut bacteria cause you to overconsume sweet or fatty foods?

A new study points to cognitive decline when consuming more than 20% of your daily caloric intake from ultra-processed foods.

Should dietary interventions be included in mental health treatment?

Fermented foods can improve the immune system and metabolism, aiding weight loss and even raising mood.

Discover how your dietary intake impacts your mental well-being.

New research finds nutritious meal delivery reduces time spent in the hospital.

In a study of more than 900 adults, researchers found that foods containing antioxidant flavonols delivered brain benefits to older adults.

Does the color of your plate determine taste perception? New research says yes.

New research finds that people overestimate how healthy their dietary intake is.

New research sheds light on how a high-fat diet may lead to pain, even in non-painful situations.

The coronavirus spurred an ongoing mental health crisis, and therapists just can't seem to keep up.

A new study shows that consuming an excessive amount of salt can contribute to elevated stress levels.

Functional foods and beverages surge in popularity, but what do these marketing terms really mean?

It turns out that knowing your way around a kitchen is good for your mental well-being.

Discover the link between sleep, the gut microbiome, and mood.

Monkeys that are more social tend to have higher levels of good bacteria in their gut. What could this mean for humans?

Could your dietary intake lead to depression? Researchers say yes.

A Mediterranean-style diet can improve your perception of stress by altering your gut microbiome.

Discover what the 'Protein Leverage Hypothesis' is and how it could help curb rising rates of obesity.

Researchers find that a "psychobiotic" diet rich in prebiotic and fermented foods may decrease stress.

Could taking a multivitamin correlate with improved brain function in older adults?

New study finds that individuals on a diet tend to overestimate the nutritional quality of their dietary intake.

New research emerges that may help to decrease obesity rates.

Think twice about ultra-processed foods — they impact both your physical and mental health.

New research sheds light on how almonds impact an individual's gut microbiome.

Could diet play a pivotal role in certain aspects of menopause? New research says yes.

Some cereal brands may have to abandon their 'healthy' status as the FDA proposes new guidelines.

Researchers describe two types of depression, both of which are associated with weight changes.

A new study reveals that the Mediterranean diet may not have the cognitive benefits long associated with it.

This animal study shows that rats can become desensitized to sweetness when consuming a high-sugar diet.

New study finds that eating during a 10-hour window and not skipping meals improves firefighter's health and well-being.

Discover five insights into why individuals with anxiety tend to fall for the latest diet trend.

New research sheds light on obesity and the impact environmental and nutritional impacts may have.

New research finds hunger is associated with increased anger and irritability

Older adults are at an increased risk of experiencing food insecurity as food prices continue to surge.

Take a look at how the past shaped our current eating habits, and how we can change our food environments to align with our appetite systems.

Discover how food insecurity affects millions of Americans and the national strategy aimed at improving the role of nutrition in overall health.

Investigating different countries' dietary habits could improve guidelines, leading to localized nutrition data.

Dietary habits may influence specific metabolites, impacting rates of cognitive decline.

A new study takes a closer look at the relationship between food insecurity and symptoms of food addiction in women.

Hormones may play a substantial role in anorexia nervosa and ARFID.

Could prescribing a healthier diet and addressing systemic barriers help the rising rates of obesity and type 2 diabetes?

Looking specifically at minorities may give rise to insights that are beneficial to everyone.

Increasing your intake of greens each day can make an impact on your mental health.

Highly processed foods promote depression, anxiety, and cognitive decline.

New research suggests that shift workers should eat exclusively during the day to prevent depression and anxiety.

New research points to how depression can lead to changes in appetite depending on the structure of an individual's reward system in the brain.

Studies suggest that the MIND diet is related to better cognitive functioning, regardless of whether an individual has amyloid buildup in the brain.

Discover how what you eat impacts both your physical and mental health.

Consuming just a cup of cranberries a day could have health benefits that include improving memory and preventing dementia.

Some experts believe that cooking can have a therapeutic role, beyond just the benefits of a healthier dietary intake.

Discover how your dietary intake can impact your affect and behavior, including how certain diets can help regulate neurological conditions.

Constantly consuming highly processed foods can impact mental health, causing anxiety and depression to rise.

From bone health to inflammation, cucumbers offer an array of benefits.

New research takes a deeper look at why parents with a low income choose to purchase unhealthy foods for their families.

Individuals with bipolar disorder saw noticeable reductions in symptoms with this diet.

While sugar alternatives may seem harmless, zero-calorie sweeteners may have a negative impact on gut health.

A healthy diet majorly determines human health by helping to regulate the immune system.

Can consumer perceptions be swayed in fibre's favor?

New research sparks discussion of what the gut-brain axis could mean for those with eating disorders.

Making grapes a part of your daily dietary intake may have a noticeable impact on health and longevity.

Consuming low glycemic index (GI) foods is a helpful strategy for managing insulin resistance.

How this essential "forgotten vitamin" may be a key factor in mood and well-being.

Ultra-processed foods high in fat and processed sugar are associated with an increased risk for dementia.

Elevated blood sugar levels can impact everything from your heart to your mental health and more.

Those who advocate for food justice see a healthy dietary intake as a human right.

Research shows that fiber is a paramount source of nutrients that your gut microbiome needs for optimal health.

New study finds that a parent's drinking history could put an individual at risk for developing food addiction.

From polyphenols, probiotics, and more — discover how to optimize your gut health.

Those with depression may be more vulnerable to the impact of inflammation induced by a poor diet as they age.

Study finds eating fruit to be more advantageous for your mental health when it comes to snacking.

Is vitamin B6 the answer to coping with stress and anxiety?

Research discovers a link between a disrupted gut and several mental health issues.

Chronically high-fat diets cause weight gain and shrink the brain, which increases the risk of mental illness for individuals with obesity.

Is self-reported hunger associated with stronger feelings of anger and irritability?

Mental health experts come together with a roadmap to incorporate nutrition into mental health treatment.

Discover how your dietary intake helps to manage anxiety and depression.

The texture of food has a significant impact on dietary intake and mood after cancer and COVID-19.

How important is the gut-brain-microbiota for optimizing mental health in young adults?

A new survey about dietary habits reveals that consumers are eating fewer fruits, vegetables, and whole grains than is recommended.

Mitigating food insecurity through student use of a campus food pantry has positive mental and physical health effects.

The incorrect assessment of diet quality proves that adults need proper education around what a healthy diet consists of.

Many people think they make healthy food choices, but they may be viewing their diet through rose-colored glasses.

Researchers show how our personal diet choices and cardiometabolic health could be significantly influenced by taste-related genes.

Is the government's strategy to reduce obesity and food poverty missing the mark?

Researchers explore how probiotics can be supportive in navigating depression, specifically depression.

Less and Less Americans are Eating Three Square Meals a Day. Does it Really Matter?

New study showcases significant differences in grey matter for those who are diagnosed with anorexia nervosa.

Explore the role anxiety plays in gut health, and what you can do to keep the two working harmoniously.

Does the eye play a role in influencing lifespan? New study links circadian rhythm, diet, lifespan, eye health, and aging.

Explore the role brain circuitry plays in regards to obesity, and look at new approaches we can take to curb overeating.

Discover how to harness probiotic-rich foods to improve not only the environment of your gut, but your physical and mental health as well.

When treating a patient with obesity, diabetes, and depression, it can be difficult to know which concern to address first.

When faced with food insecurity, studies show that people gravitate toward cheap, energy-dense meals that are bad for their health.

Your microbiome may be an important factor in your mental health. Consider these strategies to take charge of your anxiety.

Researchers may have found an alternative to sustainable weight loss that helps by improving the management of food and satiety responses.

From 2001 to 2018, there was a decrease in dietary quality among older adults in the United States.

A regular diet of junk food may play a role in unsafe driving actions among commercial motor vehicle drivers by contributing to fatigue.

New research finds that the presence of individuals from different friendship/social groups plays a role in consumers' food choices.

Researchers found an association between the consumption of a proline-rich diet with a greater tendency to develop depression.

This is the first randomized clinical trial to assess the impact of a Mediterranean diet on the symptoms of depression in young men.

This study examined relationship between protein/energy supplement in infants and mental distress later as adults.

Researchers investigated how feeling connected with the natural world benefits dietary diversity and fruit and vegetable intake.

This study may indicate that exercise can shore up restraint when it comes to certain foods

Researchers performed a RTC of a high n-3, low n-6 polyunsaturated fatty acid diet in bipolar disorder

Being angry when you’re hungry (hangry) isn’t a character flaw – it’s a scientific phenomenon

Microbes in the gut influence what an animal chooses to eat. Altering the microbiome resulted in changes to preferred diets

Eating a ton of refined sugar on the reg can increase your risk of developing anxiety and other mood concerns

There are strong correlations between what we eat and how we feel, and healthy food is happy food

New research now shows that xanthan gum affects our gut microbiota

A new study finds that eating processed meat is linked with mental and physical fatigue

Evidence exists showing the association between nutrition & mental well-being, preliminary evidence for depression

Frequent consumption of tasty/high calorie foods from cravings can have negative effects on baby's health

Researchers uncover links between the gut microbiome and personality traits – so, can nutrition change our psychology?

Center of excellence within the Department of Defense hosted a virtual program focused on nutrition therapy after brain injury

Zinc has many health benefits, including helping to reduce symptoms of anxiety and depression for some people

New research has found being confident in the kitchen is not only good for your taste buds: it’s also good for your mental health

Psychologists have often studied the negative aspects of appetite, but food is linked to some of our most positive experiences

Irregular eating contributes to poor mental health, including depression and anxiety, as well cardio-metabolic diseases and weight gain.

Our gut bacteria can influence inflammation, which is a key contributor to Alzheimer's

Not getting enough sleep can lead to a vicious circle of over-eating and further sleep deprivation

Knowing more about the relationship between chronic pain and eating behavior can help pain

A large study published in Neurology suggests that flavonoids may protect cognition

Researchers find that sadness, more than other negative emotions, can trigger cravings to smoke

Certain dietary changes can extend one’s life expectancy, a new study confirms

Circuitry in the brain responsible for motivation and pleasure is impacted when someone experiences pain

Two gut bacteria, Morganella and Klebsiella, may be connected to depression

Young adults could add over a decade to their life expectancy by switching from a Western diet

When food is used as punishment, people who once served time need intentional help to overcome the trauma

Distracted diners who stare at screens tend to eat more calories and choose fattier foods

Eating for your mental health doesn’t have to be complicated. These low-prep recipes are for the days when making a meal feels like too much

Nutritional psychiatry is the practice of using food and food supplements as alternative treatments for mental health disorders

Inadequate sleep changes what, how much, and when we eat

Too much sugar can actually be detrimental to the normal growth of the brain

Not all nutrients are created equal when it comes to engagement

Research suggests physical activity can help promote better diet

Analysis of people who eat mushrooms suggests they have a lower risk of developing depression

Excessive intake of simple sugar at puberty could be a risk factor of psychiatric disorders

In modern times, we’re often reared from a young age to use food to make ourselves feel better

Study found children aged eight or nine were more likely to be obese if their mother had a poor diet during – and before – pregnancy

The order in which the food is presented on a menu may make a difference

Young women who took four weeks of prebiotic supplements made healthier food choices and consumed less sugar

Diet drinks containing artificial sweetener may actually trigger more intense food cravings than sugar-sweetened beverages

A balanced gut has a diverse microbiota, reducing inflammation and disease

Ultra-processed diets could be playing a role in the escalation of angry rhetoric

No number large enough to provoke action when it comes to conveying the magnitude of human suffering caused by diet-related diseases

Addictive eating involves intense cravings unrelated to hunger, tolerance for large quantities of food, and feelings of withdrawal.

Research demonstrates a clear connection between nicotine withdrawal and the desire to consume high-fat, high-calorie junk foods

Data from 24,000 shows those eating mushrooms have lower odds of depression

Plant-eaters with a taste for processed foods are more susceptible to depression

Should Supplementation Be Step One in Anorexia Care?

Accredited Practising Dietitians (APD) are pushing to be officially recognised as mental health practitioners.

A new study suggests that eating alone may contribute to an increased risk of heart disease in older women

A junk food diet may increase the risk of dangerous driving among truck drivers by boosting fatigue

"Food Coma": Causes, symptoms, and prevention

Ultraprocessed foods associated with a 22% increased risk for future depression

Scientists examine whether DHA protects against carbohydrate-related effects on cognition and neuroinflammation

Every one of us must aid the effort to create a more diverse profession and discipline

Children who eat a better diet, packed with fruit and vegetables, have better mental wellbeing

Another way in which perception influences the Diet-Mental Health Relationship

Changes occurring in the gut microbiota from prolonged confinement

In an effort to extend their territory, microbes may push us to socialize

A diet designed to alter levels of specific fatty acids may help patients have less variability in mood

Scientists are now beginning to understand how microbes contribute to well-being

Canadian seniors who feel lonely consume 111 more servings of fat/year than not-lonely seniors

Study breaks down foods into three zones defined by how many minutes of health were gained or lost as a result of including them in your diet

Rebalancing the gut microbiome may be a promising step toward easing depression

Looking into history sheds insight into why dieting sets up so much struggle

Cutting sugar out of your diet can be difficult and trigger a range of unpleasant symptoms

This meta-analysis on depression in vegetarians and non-vegetarians found that on average, vegetarians had a more depressed mood

New study shows that at least 1/2 serving/day of foods high in flavonoids have a 20% lower risk of cognitive decline

Your gut-brain connection could be contributing to more than just your digestive issues.

A diet rich in fermented foods enhances the diversity of gut microbes and decreases molecular signs of inflammation

Children who consume too much sugar could be at greater risk of becoming obese, hyperactive, and cognitively impaired

Nearly 70% of St. Louis homicides last year occurred in low-income areas with no access to a grocery store or supermarket

People living with obesity who attended a non-judgemental and personalized lifestyle modification program improved their cardiovascular and mental health during just 10 weeks, according to a study

Women's mental health likely has a higher association with dietary factors than men's

Research found significant increase in depression and distress for those eating an inflammatory diet

Those who consumed more fruits and vegetables daily had lower stress levels than those who consumed less F&Vs daily

Lack of protein in the foods served at aged care centres increases risk of malnutrition. Research shows that improving the menu has pay offs

High dietary intake of animal products, processed foods, alcohol and sugar, support a gut microbiome that encourages inflammation

A new study shows sugar intake in childhood leads to learning and memory issues in adulthood

Older Americans grappling with health/cognitive declines and food insecurity

Another study demonstrating diet's effects on workplace performance and behavior

Eating highly processed foods could be associated with weight gain finds a new study

Emotional eaters had a stronger appetite response and found food to be more pleasant when experiencing negative emotions compared to when they felt neutral emotions

A new study says the next generation of 'health conscious' products should focus on food texture to enhance the feeling of being full

Canadians between the ages of 45 and 85, were less likely to exhibit PTSD if they consumed two-three fiber sources daily

New research suggests two factors closely linked with diet may be strong predictors of which children develop serious mental illness

What's the link between high sugar intake and an increased risk of developing common mental disorders in men?

Does diet play a role in regulating our fight or flight (stress) response?

The correlation between the gut microbiota and neurodegenerative disorders characteristic of Alzheimer's disease is established

New research on the role for fructose (a component of sugar) and uric acid (a fructose metabolite) in behavioral disorders

An intervention of exercise and nutritional supplementation resulted improvements in many levels of cognitive functioning in airmen

This Nutritionist is an expert in helping people plan quick and simple healthy meals and learning how to do so affordably

Dietary flavonoids from berries, apples, and other plant-based foods help protect against Alzheimer’s disease and related dementia

New research finds that increasing fruit and vegetable consumption may improve psychological well-being in as little as 2 weeks

Giving nutritional supplements to young children in low income countries for around 6 months could improve their brain (cognitive) health

Healthy eating is associated with better self-esteem and fewer emotional and peer problems

The greatest benefits come from eating 10 servings of fruits and veggies (FV) a day

Can fruits and veggies help offset the negative psychological impacts of divorce? Of unemployment?

People living in low-income households can afford to eat healthily.

A quick primer on the cognitive, addictive and mood effects of sugar

Evidence for a positive correlation between sugar and cancer, which may have far-reaching impacts on diets for cancer patients

Eating junk food can alter your brain's ability to help you regulate your junk food intake

This research study assesses self-reported food consumption in a sample of Italians during the COVID-19 quarantine

This review speculates the importance of nutrition as a mitigation strategy to support immune function amid COVID-19

More evidence that eating a healthy diet can help reduce symptoms of depression

What we eat can affect the outcome of chemotherapy because of ripple effects that begin in our gut

People who eat lots of ultra-processed foods are more likely to develop heart disease and to die sooner than those who stick with foods in their original form, two large studies conclude.

Can nutrition affect your mental health? A growing research literature suggests the answer could be yes

Fructose and sucrose can make it all the way to the colon, where they spell a sugary death sentence for beneficial bacteria

Researchers have found another good reason to eat vegetables

A high-carb diet and is associated high blood sugar is associated with cognitive decline

Psychological and behavioral therapies may be effective non-drug treatments for reducing disease-causing inflammation in the body

The first clinical trial of probiotics in bipolar disorder is out, and the results look promising

Unhealthy food seems to make the body's defenses more aggressive in the long term.

There are at least three key ways that high-sugar diets can contribute to mood, concentration, and energy problems

The variety of genes in gut bacteria is greater than 100 times the quantity of the human genome.

A study examining the impact of the Western diet and lifestyle on our immune function

Both what we eat—and how we eat it—directly influence our mental health, according to growing research

Nutritional psychiatrists counsel patients on how better eating may be another tool in helping to ease depression and anxiety and may lead to better mental health.

Aim to fill your plate with fruit, dairy, poultry, fish, and vegetables—instead of processed and fried foods—research suggests...

Frozen veggies line the freezers from top to bottom at the grocery store. But with many myths floating around today discrediting frozen...

Recent research has shown that the gut microbiome plays an essential role in the body’s immune response to infection and in maintaining overall health

Healthy eating is especially important for keeping your immune system in top condition. Here are some steps you can take to eat healthy in the times of COVID

Both what we eat—and how we eat it—directly influence our mental health

Drinking plain water is associated with decreased risk of depression and anxiety in adults: results from a large cross-sectional study

People in almost every region of the world could benefit from rebalancing their diets to eat optimal amounts of various foods and nutrients

Dark chocolate lowers the risk of depression, according to a cross‐sectional survey of over 13,000 US adults

The evolution of dietary and hygienic habits in Western countries is associated with a decrease in the bacteria that help in digestion.

Diet is an important risk factor for cancer that is amenable to intervention.